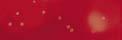

INTERVIEW
















![]()




































SCHEIDINGSGERUCHTEN OBAMA’S !
























Scan voor meer receptinspiratie
www.mekkafood.com/nl/inspiratie













































































































































































































































































Imagine this: een Big Americans pizza, maar dan extra large. De Big Americans XL is verkrijgbaar in de smaken Triple Meat en Double Pepperoni. Een ware smaakexplosie voor de vleesliefhebbers onder ons. Heb jij hem al geprobeerd? Probeer Big Americans XL nu!










Entertainment
12 Michelle Obama
22 Society Journaal
28 Columnist Rob Goossens
60 7 vragen aan Cheyenne Aldus
64 Sven Versteeg
68 In de hoofdrol: Sabrina Carpenter
20 Hip & Hot
42 Koken met Sharon en wijnadvies van David
48 Op reis naar de Caribbean 54 Eropuit
56 Sietskes Oogappels
32 Huishoudbode
38 Groen geluk
76 Intiem met Lieve
82 Dierenwereld
86 Kits





Va n de B a h a m a’ n aa r K aa im ei la nd en on en David els e
Bahama’s naar de Kaaiman-











Sabrina Carpenter daagt uit
















60


Lieve geeft advies over liefde & lust ov er l ie fd e & lu st









Cheyenne: ‘In de ring ben ik The Destroyer’


Wie Sven Versteeg wil interviewen hoeft niet langs een manager. Geen mailtjes naar info@boekingenpunt.nl, geen secretaresse die eerst even checkt of je wel relevant genoeg bent. Je mailt gewoon Sven zelf. De man achter Blikkendag, de grootste Nederlandstalige meezinger van dit jaar, is razenddruk sinds zijn doorbraak, maar regelt zijn administratie, boekingen en pr nog steeds zelf.
En ondertussen: vierhonderd optredens per jaar, een gezin thuis, en een stem die koste wat kost intact moet blijven. „Ik ben er klaar voor om dingen uit handen te geven”, zegt Sven. „Maar het is lastig. Het is mijn kindje.” Een doorbraak is zelden toeval. Wie Sven hoort praten over zijn vak, hoort geen popster, maar een gedisciplineerd vakman. Hoe dat klinkt? Lees het hele interview vanaf pagina 64.
Aan de andere kant van de oceaan ziet het artiestenleven er nét even anders uit. Neem Sabrina Carpenter. Haar nieuwe, gewaagde albumcover bleek genoeg om het halve internet in een preuts coma te jagen. Voor wie het wat al te gretig in beeld vond, kwam Carpenter met een alternatief: een brave zwart-witfoto. Haar succes is in dollars en liefdadigheid uit te drukken: tijdens haar tournee haalde Sabrina in minder dan een jaar tijd een miljoen op voor goede doelen.
Verder in deze editie: Michelle Obama gooit het presidentsvrouwenjasje van zich af, haring happen op Nijenrode en eilandhoppen tussen de Bahama’s en de Kaaimaneilanden.
Anette de Vries



Elke maand meer dan 3,5 miljoen kijkers!







Wil jij ook op deze pagina verschijnen?
Stuur een e-mail naar: commercie@trustedmedia.nl

DenD geeft 3× 2 kaarten weg voor Doekje voor het bloeden.* Ga naar DenD.nl/winnen om kans te maken.
*Datum naar keus op basis van beschikbaarheid.

Te zien in het hele land:

Na drie uitverkochte reünieconcerten in De Kuip keert de grootste Pink Floyd-tributeshow van Nederland terug. Dit keer met 30 jaar PULSE. Een spectaculair eerbetoon aan het legendarische livealbum PULSE, dat dertig jaar geleden uitkwam. De show is te zien op 5 en 6 september in RTM Stage Rotterdam. PULSE bevat de registratie van de 1994 World Tour. Deze laatste tour van Pink Floyd werd wereldwijd door miljoenen fans bezocht. pulse.ntk.nl
WINNEN!
DenD verloot 2X 2 kaarten voorPinkFloyd ProjectPresents:PULSE 30YEARS!Ga naar DenD.nl/winnen om kans maken.te


WINNEN! DenDverloot3X dekleurrijkeetuivan MrsdeJong.Ganaar DenD.nl/winnen om kans te maken.


Doekje voor het bloeden is een muzikale, tragikomische voorstelling over hulp, goede bedoelingen en de vaak absurde verhalen achter armoede. Vijf acteurs strijden om jouw barmhartigheid voor de thuisloze Willem, een rol van Yasmina Abdelmoumen. Zij laat zien hoe iedereen met genoeg tegenslag (een) Willem kan zijn of worden. De voorstelling, een co-productie van George Tobal Producties en het NUT, toert van 4 september t/m 24 november langs theaters in het hele land. georgetobalproducties.nl
*Datum naar keus op basis van beschikbaarheid.



Het Nederlandse merk MrsdeJong maakt vrolijke toilettassen, etuis en shoppers met zorg en vakmanschap. Perfect voor vrouwen die houden van iets unieks en geen massaproductie willen. De 69-jarige 'old entrepreneur' Jeannet van der Knaap werkt nog elke dag met plezier in haar atelier. Aan haar kwalitatief hoogwaardige producten heb je jarenlang plezier! mrsdejong.nl









Uit onderzoek blijkt dat twintig gram extra vierge olijfolie per dag het immuunsysteem ondersteunt, helpt bij het verlagen van cholesterol én bijdraagt aan een gezond hart en een stralende huid. Dat binnenkrijgen wordt gemakkelijk met deze 100 procent natuurlijke olijfshot, gemaakt van Sardijnse extra vierge olijfolie. olivious.com WINNEN! DenD verloot 3X de Olivious olijfolie. Ga naar DenD.nl/winnen om kans te maken.

WINNEN! DenDverloot10X TerugopdeAchterbank. Ganaar DenD.nl/winnen omkanstemaken.

Tactiek, lef en dobbelgeluk, dát is Popnagelen! Dit verslavend leuke spel is gemakkelijk te leren en onmogelijk om weg te leggen. Voor jong en oud dé perfecte keuze voor elke spelavond. Versla je vrienden met slimme zetten en zie hoe elke worp het verschil kan maken. Speel je eerste potje... als je durft! popnagelen.com
NIET GEWONNEN?
Bestel het spel met 10% korting met de code DenD2025.


‘Ik ben tweeënveertig jaar, mijn relatie is voorbij en ik kom net uit een depressie. Toen mijn moeder vroeg of ik het gezellig zou vinden om mee te gaan naar een huisje in de Auvergne, heb ik ja gezegd.’ De hoofdpersoon in Terug op de achterbank gaat op aandringen van een goede vriendin mee met zijn ouders op zomervakantie. Als vanzelf nemen zowel de zoon als de vader en moeder hun oorspronkelijke positie binnen het gezin weer in, alsof er niet een half mensenleven voorbij is gegaan. Terug op de achterbank observeert hij zijn ouders en ondergaat hij opnieuw de geborgenheid die het liefdevolle gezin hem altijd heeft geboden, maar ditmaal met andere ogen. deharmonie.nl WINNEN!DenD verloot 2x het dobbelspelPopnagelen . Ga naar DenD.nl/winnen om kans maken.te






























































VOL VAN SMAAK, HOOG IN PROTEÏNE














START GOEDE EETLUST





WEEK 1 HOOG

ENERGIENIVEAU








WEEK 2
VERBETERD DARMMICROBIOOM

WEEK 3
GLANZENDE

VACHT & HELDERE OGEN





Ik wil leven! ik wil vrij zijn! Michelle Obama schreeuwt het van de daken. Ze is 61 en begonnen aan haar éigen leven. Ze heeft de zwachtels van zich afgegooid, schudde haar hoofd en kneep in haar arm. Michelle ging naar een andere kapper, die een gevlochten mohawk in haar haarbos toverde. Het is alsof Michelle opnieuw werd geboren.









Na de jaren als presidentsvrouw heeft Michelle La Vaughn Robinson zichzelf herontdekt als individu. Ze wil niet meer vastgelijmd zitten aan haar zorgvuldig opgebouwde imago of aan haar man Barack, de 44ste (ex-) president die in de Verenigde Staten een cultstatus heeft bereikt. Michelle wil vrij zijn, net zo vrij als een vogel...
Het is hetzelfde gevoel dat veel vrouwen tekent als ze decennialang hun man hebben ondersteund. Het wegcijferen,

2008:de Obamadochters werden veelvuldig ingezet tijdens campagnes.
het ondersteunen in moeilijke tijden en in sommige gevallen volgde er ‘als dank’ nog een wisseltruc. Manlief ruilt zijn eerste liefde in voor een nieuw exemplaar.



Dit is de meest recente foto van het gezin



In de Verenigde Staten draait de geruchtenmachine rond de Obama’s op volle toeren. Telkenmale duikt er een verhaal op dat het over en uit is tussen het droomkoppel Barack en Michelle. Vooral ook na enkele interviews van Michelle, die zelf volop aanleiding gaf voor speculaties. De geruchten over een mogelijke scheiding van de Obamas liepen op toen Michelle begin dit jaar niet aanwezig was












bij de tweede inauguratie van Donald Trump – wat op sociale media leidde tot geruchten over een mogelijke breuk. Ook bij de uitvaart van voormalig president Jimmy Carter zat Barack zonder zijn echtgenote in de rij met Donald Trump en ex-presidenten.
Hoon en kritiek
Michelle reageerde fel op de geruchten: „Mijn beslissing om de inauguratie over te slaan en om begin dit jaar keuzes te maken die goed voor mij voelden, werd met zoveel hoon en kritiek ontvangen,” zei ze.

„Mensen konden niet geloven dat ik gewoon















In 2012 over de kracht van vrouwen:
“ER IS GEEN GRENS AAN WAT WIJ , ALS VROUWEN , KUNNEN BEREIKEN”


Sasha krijgt een dikke zoen van papa Barack, Malia Ann kijkt toe.
een voorbeeld voor mij en Barack als stel.”
Michelle legde uit dat zij en Barack leren van hoe Bruce en Patti met elkaar omgaan, onder meer als het gaat om communicatie: „We kijken naar hoe jullie eraan werken, en we krijgen advies over hoe je de lijnen van communicatie openhoudt.’ Ze prees het stel als ‘twee krachtige mensen’ en ‘machtige individuen op zichzelf, die hun levens samenbrengen”. Maar er zijn meer scheuren aan het Obama-front. Ook de twee dochters Malia (26) en
In
2016 over gemene aanvallen van Donald Trump:
“ALS ZIJ LAAG GAAN , GAAN WIJ HOOG”
Sasha (23) creëerden afstand naar hun twee beroemde ouders. In de podcast van Kate en Olivia Hudson vertelde Michelle dat haar dochters zich al tijdens hun tienerjaren bewust begonnen af te zetten tegen haar en hun vader.
„Onze dochters zijn nu volwassen vrouwen, maar in hun tienerjaren maakten ze echt een periode door van afstand nemen. Het was het klassieke wegduwen.” Dat blijkt ook uit Malia’s opvallende keuze om haar achternaam te
➜ nee zei. Ze namen aan dat mijn huwelijk uit elkaar was gevallen.” Maar onlangs leek er toch iets meer aan de hand. Zanger Bruce Springsteen en diens vrouw Patti Scialfa blijken ‘huwelijksmentoren’ te zijn van de Obama’s, zo onthulde Michelle zelf. „Ik ben vol bewondering voor jou en Patti en het werk dat jullie samen hebben verricht,’ vertelde Michelle aan Springsteen. „Jij en Patti zijn al geruime tijd
Toen was geluk voor de Obama's nog heel gewoon.
Drie generaties op rij. Michelle en haar dochters en rechts haar moeder Marian.




Michelle Obama mag dan misschien soms twijfelen over haar relatie met haar man Barack, maar de schoorsteen moet natuurlijk wel blijven roken. De Obama’s werden na het vertrek uit het Witte Huis een ware geldmachine. Michelles boek Becoming werd een internationale bestseller.
Aan de boekendeal met een uitgever hield ze een slordige 65 miljoen dollar over. Ook van hun lezingen kunnen ze de boodschappen goed betalen: voor een gage van tussen de tweehonderd- en vierhonderdduizend dollar komen de Obama’s bij je langs. Het koppel woont afwisselend in Washington D.C. en op Martha’s Vineyard. De huizen zijn destijds aangekocht voor een totaalbedrag van bijna 20 miljoen dollar. Volgens schattingen is het nu 10 miljoen dollar meer waard.
joen dollar. ngen is het nu r meer waard.
en bijdragen aan podcasts van Michelle sluiten naadloos aan op de nieuwe publicatie in november van dit jaar. Michelle is aan een nieuw leven begonnen en is daarmee boegbeeld van een nieuwe emancipatiegolf. Ben je bevrijd van je mans carrière en je blijft achter met een leeg nest nu het kroost is uitgevlogen, dan zijn de resterende jaren helemaal van jou. Desnoods zonder partner als dat past bij de ontdekking dat je nog steeds een eigen leven hebt.



dijilijk d
definieert. de jaren dat in het Witte

Marketingmachine
Naar haar volgende boek
gmachine ende boek
Michelle: „The Look gaat over meer dan mode. Het gaat over zelfvertrouwen. Over identiteit. Over de kracht van echtheid. Mijn hoop is dat dit boek gesprekken op gang brengt over hoe we onszelf zien en over hoe onze samenleving schoonheid definieert. Tijdens de jaren dat mijn gezin in het Witte Huis woonde,
werd mijn uiterlijk constant onder de loep genomen. Wat ik droeg, hoe mijn haar zat, alles werd geanalyseerd en bekritiseerd. Maar ik was méér dan een outfit of een kapsel. Al een tijd voelde ik de behoefte om dat verhaal te vertellen, op míjn manier.”


Om te w
Huis om te u




t zou om een k epos gaan, e orden e kunt
The Look wordt reikhalzend uitgekeken. Het zou om een zeer persoonlijk epos gaan, waarin de diepe gevoelens van Michelle worden gepubliceerd. Je kunt ook stellen dat de marketingmachine van de Obama’s weer op volle toeren draait.








Want de interviews
ine s ews










Michelle is dankbaar dat ze nu op een punt in haar leven is gekomen waarop ze zich vrij voelt om zichzelf te uiten zoals ze wil. Om te dragen wat ze mooi vindt. Om te doen wat goed voelt. En om open te zijn over de reis die haar hier heeft gebracht.„Het is een persoonlijke reflectie op mijn levenslange band met mode, haar en schoonheid. Je vindt er outfits die veel voor me betekenen, maar belangrijker nog: de momenten die eraan verbonden zijn. Groot en klein. Persoonlijk en politiek. Historisch en alledaags. Momenten die me zijn bijgebleven, net als de kleding die ik toen

Om te doen wa om open te zij haar hier hee is een persoo op leve haar e er outfit betekenen, m nog: de mo verbonden Groot en k en politiek alledaag me zijn als de kl droeg.”




































































Als er iemand Donald Trump in 2024 had kunnen verslaan dan was het wel de immens populaire Michelle Obama. De huidige president van de Verenigde Staten was beducht voor de voormalige presidentsvrouw. Michelle heeft er echter nooit wat van willen weten. Vier jaar Witte Huis, na de periode van acht jaar met Barack in The Situation Room, trekt haar niet. Maar toch liet ze zich niet onbetuigd op de achtereenvolgende congressen van de Democratische Partij. Haar vele fans stonden op de banken en applaudisseerden hun handen blauw. Maar Michelle is onvermurwbaar. t

laten vallen toen ze vorig jaar haar korte film presenteerde op het prestigieuze Sundance Film Festival. „Wij zeiden: ‘Ze gaan toch wel weten dat jij het bent, Malia.’ Maar we respecteerden haar poging om haar eigen pad te volgen”, aldus Michelle. „Elke zaterdagavond was een nachtmerrie. Zelfs een bezoekje aan een vriend thuis betekende dat de Secret Service eerst het huis moest doorzoeken op wapens en drugs. Je moet als ouder twee keer zo hard werken om hun leven normaal te laten lijken.”
Heel normaal Nu haar dochters volwassen zijn, ligt Michelles focus op het loslaten. „Wij noemen het de
Volwassen en weg bij hun ouders: ze staan op eigen benen. MICHELLE WIL



Obama-belasting. Ze zullen er hun hele leven mee te maken hebben, maar er zitten ook voordelen aan”, zei Michelle. ,,Ik probeer het zo normaal mogelijk te houden voor hen. Ik wil niet dat ze denken dat dit allemaal om hen draait.”
Malia en Sasha wonen in Los Angeles, waar ze hun eigen leven proberen op te bouwen –ver weg van Washington D.C. en hun ouders. Michelle ziet hoe
In 2020 over haar ervaringen op het wereldtoneel:
“IK HEB AAN ELKE MACHTIGE TAFEL GEZETEN
DIE JE MAAR KUNT BEDENKEN EN GELOOF ME ... ZE ZIJN NIET ZÓ SLIM”
haar dochters hun zelfstandigheid koesteren en benadrukt dat zij en haar man, de ex-president, hen daarin ondersteunt, hoe moeilijk het soms ook is als ouders. „Ze doen het goed, maar ze willen duidelijk hun eigen plek in de wereld creëren, zonder dat alles om ‘de Obamas’ draait.”









































Heerlijk hè, die lange zwoele zomeravonden waar geen eind aan lijkt te komen. Maar ook als het afkoelt, willen we zo lang mogelijk van de tuin genieten. En dat kan prima, met een deken of plaid bijvoorbeeld. Die houdt je niet alleen comfortabel warm, maar geeft ook een knus gevoel. Voor een gezellig kampvuursfeertje steek je een vuurkorf aan. Heb je geen zin in rookgeur in je kleding, ga dan voor een heater.
eater










Tijdens frisse zomeravonden is een comfortabele plaid het beste gezelschap. ‘Lieke’ van Unique Living is gemaakt van heerlijk zacht polyester, 160 x 130 cm groot en verkrijgbaar in diverse kleuren.
ode gasten
Een groot nadeel van buiten zitten, zijn die vliegende en zoemende insecten om je heen. Om niet door muggen gestoken te worden, smeer je je onbedekte huid in met deet en steek je citronellakaarsen aan. Of je plant citroenmelisse, citroenverbena, Afrikaantjes of lavendel in de tuin, want daar houden muggen niet van. Ook van de pepermuntplant zijn ze geen fan. Vliegen, mieren, spinnen en wespen ook niet trouwens. Die laatste engerds blijven ook op afstand door verderop in de tuin wat zoetigheid neer te zetten.
nadeel van buiten zitten, egende en zoemende m je heen. Om niet door estoken te worden, onbedekte huid t en steek je aarsen aan. Of roenmelisse, bena, s of lavendel want daar uggen ok van untplant n fan. eren, spinnen ook niet
Die laatste op afstand door n de tuin wat neer te zetten.





Na een dagje opladen in de zon voorziet deze decoratieve, ijzeren lantaarn met antieke afwerking je tuin ’s avonds van warm en sfeervol licht. Van Loberon.
Na een zo dec la a ’ e V

Het is nergens zo heerlijk luieren als in een hangmat. Dit fraaie exemplaar van HK Living is gemaakt van zacht, maar stevig katoen en heeft een royaal formaat van 210 x 115 cm. Optimaal ontspannen dus.





Het knisperende geluid, de dansende vlammen waar je eindeloos in kunt staren… Een fijn vuurtje is toch wel de gezelligste warmtebron die er is. Deze gietijzeren vuurschaal ‘Fancy Flames’ bezorgt je mooie zomeravonden. Van Esschert Design.






Lekker loungen in de tuin vraagt om een fijn muziekje. De duurzaam gemaakte Roots Bluetooth speaker van House of Marley zet je neer of hang je op waar je maar wilt. Flesopener vergeten? Geen probleem, want deze waterproof speaker heeft een ingebouwde flesopener.






De Barolo wijnkoeler van Leopold Vienna met duurzame bamboe behuizing en roestvrijstalen, vaatwasmachinebestendige binnenemmer houdt jouw favoriete zomerdrankje in stijl de juiste temperatuur.















Botan Takada: magistraal op de cello naar de eerste plaats van het Concours.











Achter de deuren van de Kleine Zaal van Het Concertgebouw speelde zich een klein wonder af. Daar stond een meisje van twaalf jaar, cello in de hand, met een overtuiging en muzikaliteit die je eerder bij een doorgewinterde solist zou verwachten. Haar naam: Botan Takada. Haar prestatie: winnaar van het prestigieuze Koninklijk Concertgebouw Concours 2025.
Botan Takada, leerling van het Gymnasium Haganum in Den Haag en celloleerling van Matthijs Broersma liet in de finale met een Bach-prélude en het virtuoze Impromptu van Arutiunian horen dat muziek geen leeftijd kent. „Je pakt de zaal in. Hoe meer mensen er zijn, hoe beter jij gaat spelen,” aldus een zichtbaar onder de indruk zijnde juryvoorzitter en dirigent Vincent de Kort. ,,Je ontsteeg je leeftijd. Je nam ons écht mee.” Het Koninklijk Concertgebouw Concours, dat








inmiddels zijn zeventiende editie beleeft en mede mogelijk wordt gemaakt door de VandenBroek Foundation, is bedoeld voor jonge musici tussen de negen en veertien jaar. Die zaal vol mensen voelde voor Botan Takada als thuiskomen:
„Met cello kan ik al mijn emoties uitbeelden, blij, boos, verdrietig… en het leukste: grappig”, vertelt ze met fonkelende ogen. „Ik had gewoon niet verwacht dat ik eerste kon worden.
Ik ben zó Ik heb meteen mij
Ik ben zó blij. Ik heb meteen mijn muziekdocent gebeld om het te vertellen!”

Plezier stimuleren










Botan Takada werd bedolven onder de prijzen én felicitaties.

De weg naar de finale begint laagdrempelig: ruim tweehonderd jonge talenten deden dit jaar mee via een digitale voorronde op YouTube, waarbij álle muziekstijlen welkom zijn. „We willen vooral het plezier in muziek maken stimuleren”, zegt een woordvoerder van Het Concertgebouw. Een speciaal georganiseerde workshopdag trok 137 jonge deelnemers,
De weg naar de finale begin ruim tweehonderd ta mee via een digita álle welkom „We will in muziek ma zegt een woordvoerd Het Concertgebouw. geor w tr d

















Gefeliciteerd Botan!





















Twaalfjarig talent



Anna van den Houten (13), beginnend jazz-zangeres, in de finale van het Concours.
met inspirerende sessies van onder anderen componist Oene van Geel en musici van het Jong Nederlands Blazers Ensemble.
Finale vol kleuren












Raelene Pramana spelend op viool.




Amy Nassereddine in de finale op de alt sax.






De 14-jarige Thaevan
Yap op drums. Na de zomer gaat hij studeren aan het Codarts Lyceum in Rotterdam.
De finale in de Kleine Zaal, was misschien wel de meest veelzijdige tot nu toe. „We hadden jazz, klassiek, slagwerk, blazers… alles kwam voorbij”, aldus jurylid en violist Julia Philippens. „Dat maakt het lastig vergelijken. Maar we kijken uiteindelijk naar één ding: raakt het je?” In de jury zaten verder onder meer meesterpianist Thomas Beijer, saxofonist Mete Erker en zangeres Izaline Calister. Zij kozen unaniem voor Botan.
Als winnaar ontvangt Botan niet alleen een geldprijs van €1000 voor haar muzikale ontwikkeling, maar mag ze ook optreden tijdens een lunchconcert in Het Concertgebouw en op het Grachtenfestival, samen met de andere finalisten. Maar haar dromen reiken nog verder: „Later wil ik met het
Concertgebouworkest spelen. Omdat iedereen daar zó goed speelt, en ik wil van hen horen wat hun instrument voor hén bijzonder maakt.”
Toekomstmuziek
Botan in een ind
Botan voegt zich met haar winst in een indrukwekkend rijtje: eerdere winnaars zijn onder anderen fluitist Lucie Horsch (2009) en pianist Nikola Meeuwsen (2014), die recent nog furore maakte als winnaar van de Koningin Elisabethwedstrijd in Brussel. Wat de toekomst Botan brengt? Als het aan haar cello ligt, alles. Maar voor de jonge celliste blijft het vooral verwondering. Het is zoals juryvoorzitter Vincent de Kort het verwoordde: „Zelden zie je iemand zo natuurlijk op het podium staan. Botan wás de muziek.”
(fotografie: Het Concertgebouw)

Amazoneleider
Dadá Borari kreeg de Prix Voltaire uitgereikt door voormalig Navo-baas Jaap de Hoop Scheffer.




De naam van de dwarsligger als het gaat om klimaatbeleid werd bij de uitreiking van de prestigieuze Prix Voltaire 2025 resoluut gemeden. Donald Trump, de Amerikaanse president, hing als een donderwolk boven Huis ter Duin, waar de charismatische Amazoneleider Dadá Borari werd gelauwerd met de Voltaireprijs.
Met een indianentooi op zijn hoofd aanvaardde DadáBorari de prijs.
Zijn fans in de zaal lieten zich niet onbetuigd, overwinningskreten vlogen over de tafels. Het bestuur van de prijs, met René van Ass als voorzitter, voormalig champagne-baas Bob Bron directeur Stephan Stokkermans als leden, hadden een mooi gezelschap bij elkaar gebracht. Voormalig Navo-topman Jaap de Hoop Scheffer reikte al voor de vijfde keer op rij de prijs uit. De CDA’er deed een oproep aan de politiek: „De hogere uitgaven voor Defensie mogen niet





ten koste gaan van duurzaamheid.” Dat de Nederlandse Douane wat minder ontzag heeft voor tradities in het Amazone-gebied bleek wel uit de anekdote dat de grenswachten eerder de originele indianentooi van Borari hadden ingenomen, omdat er veren waren gebruikt van zeldzame vogels. Borari trok echter toen hij naar het podium werd geroepen een indrukwekkende reservetooi uit zijn tas. De menukaart van deze avond in Huis ter Duin was vleesloos, terwijl de ‘normale’ wijnen van Hollandse bodem afkomstig waren. Dat is wennen, maar de afdronk van een alcoholvrije 100 procent Riesling van Geierslay beviel.

Voorzitter René van Ass met links Tom Wheeler, voorzitter Treesistance, die de strijd van Dadá Borari (midden) ondersteunt. er, n en hotelermans oi acht. ap de or :





Stephan Stokkermans reikt een speciale aword uit aan hotelexpert Onno Poortier (l.)





Kritisch VVD’er Ed Nijpels en society-koning van het Stan Huygens Journaal, Pieter Klein Beernink, krijgen gerookte zalm op een toastje aangeboden.

Alan van Griethuysen (links), CCO NPEXeffectenbeurs,midden Jan Kluft en rechts Mark van der Plas, CEO van de NPEX-effectenbeurs.



‘Hollandse Nieuwe’, schalde het door de luidsprekers in het walhalla van de haringparty’s in Nederland. De Nationale Haringpartij, terug op het terrein van universiteit Nijenrode in Breukelen, waar de vorige minister van Economische Zaken Micky Adriaansens de scepter zwaait. Nogal volks dus, en toen we society-influencer Willem Kool zagen smikkelen van een bak kibbeling wisten we het helemaal zeker. Ook de beste haringparty van het land nivelleert.
MSocietyinfluencer Willem Kool aan de kibbeling.













De Haagse burgemeester Jan van Zanen met zijn rechterhand Annelou van Egmond.


society-ladys:

CCO A CEO Mar van de Zaanse b
AlanvanGriethuysen
Alan van Griethuysen en Mark van der Plas, op uitnodiging van de Zaanse belegger Jan Kluft met zijn bedrijf Paerel, bleken haringfans.
et VVD’er Ed Nijpels, werd het politiek gemeenschapsspel gespeeld: wie gaat straks met wie. Een coalitie met VVD, JA21, CDA en D66 komt steeds dichterbij. Maar de PvdA en GroenLinks sluit Ed nog steeds niet uit. In Breukelen waren er geen leden van het Koninklijk Huis, geen ministers en staatssecretarissen van het kabinet-Schoof, maar wel veel vertegenwoordigers uit het bedrijfsleven. Dat is jammer, want haring is er voor alle rangen en standen. Bijvoorbeeld de directietop van NPEX-effectenbeurs was er wel.
Er werd zelfs haring-ijs uitgeserveerd. Verder was het goed toeven tussen de haringspecialisten, zoals de haringkoninginnen Debby en Sabrina uit Obdam. Uit Maarsen stal Harry van Goor en zijn dochter Janneke en zoon Chris de show. Janneke maakt de haring schoon met een innovatief mesje. Resultaat: geen graatjes meer in de haring.
„Ik begin er niet meer aan”, aldus Harry, die met blote handen de haringen kaakt. „Ik masseer de haringen, zonder dat ik er zelf erg in heb.” ■
DenD welkom op uw party?
Stuur uw uitnodiging naar: redactie@dend.nl






























De podcast-hype is een zegen voor wie kletskousen wil afwimpelen. ,,Heb je al eens aan een eigen show gedacht?”, kun je tegenwoordig met een glimlach zeggen. Tot ze het echt doen en we allemaal opgescheept zitten met het eindeloze gebabbel van BN’ers, zoals Leontine Ruiters, die bewijzen dat zwijgen soms écht goud is. Er was een tijd dat de Borsatootjes volledig uit de media verdwenen waren. Pater familias Marco zal dat advies wel hebben gekregen van zijn advocaten nadat het Openbaar Ministerie besloot om hem te vervolgen voor het vermeende misbruik van een minderjarig meisje. Maar ook zijn ex-vrouw Leontine en zijn kinderen, die toch niet in de eerste spotlight gestikt zijn, waren ineens nergens meer te bekennen.
Nu de zittingen er eindelijk aan komen, begint een deel van het gezin zich echter weer te roeren. Dochter Jada (22) plaatst op instagram routineus hartjes en vlammetjes onder foto’s van baby’s, break-up posts, en mensen die slecht nieuws hebben gekregen van de dokter. Irritant, maar helaas niet uniek. Werkelijk al onze sterren kunnen zich op sociale media vrijwel
alleen nog met gemakzuchtige icoontjes uitdrukken. Alsof iemand ze heeft verteld dat de mensjes een beetje empathie wel leuk vinden, maar het toch allemaal niet te veel energie moet kosten.
Marco Borsato zelf is ook weer actief op sociale media. Beelden van motortripjes wisselt hij af met curieuze videobewerkingen waarvan je je afvraagt of hij nou iedereen voor de gek houdt.
Maar niemand in het gezin overtreft Leontine. Zo heeft ze een podcast met een vriendin waarin ze wekelijks bewijst hoe leeg haar leven is.
Ze ‘beïnvloedt’ op sociale media iedereen over borrelplanken, elektrische fietsen en vakanties. En ineens duikt ze ook op in interviews.
Zo vertelt ze in de podcast Leergeld hoe lastig ze het vond om na de scheiding van haar Marco financieel weer op eigen benen te moeten staan.
Hoe ‘lastig’ dat dan was, onderstreept ze met de onthulling dat ze in de supermarkt nog steeds ,,wel een beetje oplet”. Maar: ,,Het is niet zo dat ik echt elk pak met elkaar vergelijk ofzo, dat niet.” Scroll voor de grap even door de foto’s van haar nieuwe huis op instagram: het is haar allemaal van harte gegund, daar niet van, maar een douchekraan van €1800 is

Leontine, klaar voor 48 uur zonder filter in Het Waren Twee Fantastische Dagen.



niet wat ik mij persoonlijk voorstel bij iemand die wel een beetje oplet Zo gemakkelijk kletsen en zo’n groot bord voor de kop hebben, is natuurlijk goud voor reality-televisie. Het zou mij eigenlijk niets verbazen als John de Mol zijn nieuwste programma-idee Het Waren Twee Fantastische Dagen (SBS6) speciaal voor Ruiters bedacht. Drie BN’ers brengen 48 uur met elkaar door in een huis zonder presentator, en moeten dus zelf de tijd volpraten. Met Ruiters in het huis weet je van tevoren: haar kinderen gaan zich doodschamen als ze het resultaat onder ogen krijgen, maar de kijker vindt het vast geweldig.
Demonen
En zo geschiedde: Leontine vertelde in geuren en kleuren hoe ze tijdens een ayahuasca-ceremonie met haar ‘demonen’ begon te knuffelen. Snikkend om een complimentje van niks (ja, echt) klopte ze zichzelf op de borst over hoe sterk ze eigenlijk was. En als klap op de vuurpijl moest de kijker aanhoren dat ze haar huid met zalmsperma laat behandelen. Ik herhaal voor de zekerheid nog maar even: er kwam geen presentator aan te pas. Geen Wendy van Dijk die geduldig maar geslepen naar Leontines diepste wonden toekletste. Geen Sven Kockelmann die haar net zo lang onder



schot hield tot ze de wonderlijkste teksten begon uit te kramen. Er waren alleen twee tijdelijke huisgenoten, Frank ‘467 kilo coke’ Masmeijer en Monique ‘André Hazes junior’ Westenberg, die allebei braaf meeknikten.
Het tragische is: ze denkt waarschijnlijk écht dat ze een sterke vrouw is, en niemand die er nog tussen kan komen. In de podcast waar ik haar al eerder uit citeerde, vertelde ze namelijk dat ‘het haar niet raakt’. ,,Als iemand het over mij heeft en het is negatief, dan is dat een reflectie van zichzelf op mij. Het is niet van mij. Dus het doet me niet zoveel.” Marco Borsato zal dit najaar voor het hekje plaatsnemen. Eindelijk. Plots dwalen mijn gedachten naar een opgelucht stemmetje, dat toch zeker een steeds grotere kamer moet huren in Borsato’s achterhoofd. 'Een gevangenisstraf is natuurlijk geen pretje, Marco. Maar dan ben je in elk geval even bevrijd van dat geneuzel over zalmsperma.' ■





















EMILE BODE


Fietsvakantie in ZuidLimburg: Emile met zijn oudste dochter en kleinzoon Guus.


De vakantieperiode is in volle gang. In de eerste week van augustus komt Nederland tot stilstand, tenzij er iets vreselijks gebeurt.
Als deeltijdpensionado vermijd ik de zomerdrukte. Maar onlangs belandde ik toch per toeval met vrienden op Texel!
Wij pensionado’s zijn bevoorrecht: we kunnen eropuit in de ‘goedkope’ periodes. Begin mei waren er drie schitterende dagen, en we boekten last minute ons lievelingshotel in Twente voor een fietsvakantie. Het arrangement was €350 goedkoper dan in het hoogseizoen. Twee weken later volgde opnieuw een midweek met fantastisch weer.
We besloten op het laatste moment naar een mooie vakantiewoning op de Cauberg te gaan. Onze oudste dochter en kleinzoon Guus kwamen ook logeren. Dat scheelde €266 ten opzichte van augustus.
Voor eind november heeft mijn jongste dochter samen met haar echtgenoot opnieuw geboekt: we
gaan met z’n vieren, net als vorig jaar, naar de Duitse kerstmarkten. De Krakauer Bratwürste zullen ons weer goed smaken. Het appartement is dan ook nog eens €410 goedkoper dan in deze maand. De prijsverschillen zijn schrikbarend groot. Ik heb dan ook medelijden met Jan Modaal en zijn twee kinderen. Willen zij in het hoogseizoen naar een huisje in Port Zélande, dan
betalen ze zomaar het dubbele van wat je kwijt bent in de rustige ‘pensionadomaanden’.
Vakantie is voor veel mensen onbetaalbaar geworden, tenzij je iets weet te regelen. Of je reist af naar een land waar het leven nog voordelig is. Of je hebt geluk met een lastminute-aanbieding. Zo huurden twee echtparen in augustus vorig jaar een oud, maar schoon huisje met goede bedden in Drenthe. Een volle week voor een luttel bedrag.
Alles is duurder geworden, ook in de horeca. Toch heb ik voor u een lijstje met goed geprijsde restaurants. De meeste heb ik zelf getest. Denk aan De Pizzabakker, Happy Italy, Bregje en mijn favoriet: Montimar, met zes vestigingen in Noord-Brabant. Als je de menukaart bekijkt, geloof je je ogen niet. Het eten was uitstekend, en de bediening al even vriendelijk.
In Brabant en elders in ons land zijn de prijzen over het algemeen nog enigszins acceptabel. Maar als u de warmte in het zuiden van Europa zoekt, bent u een gewaarschuwd mens. Vlak bij Saint-Tropez staat nu een lastminute te huur voor een week: een eenvoudig zespersoons villaatje en niet eens aan het strand. Voor vijf rode ruggen is het villaatje van u. Ik wacht wel op de volgende aanbieding...




Een delicatessenwinkel in het Haagse stadsdeel Benoordenhout, volledig gespecialiseerd in Franse producten. Is dat niet heerlijk?
Estelle Cohen Solal komt oorspronkelijk uit Parijs en heeft een carrière als IT-projectmanager achter de rug. Ze trouwde met de Nederlander Rob Cornegge. Als gepassioneerde fijnproevers begonnen zij in 2022 met Les Belles Saveurs, zeg maar: ‘de mooie smaken’. Mét een uitstekende webshop, zodat u vanuit alle hoeken van het land heerlijke producten kunt bestellen.
De versproducten zijn overigens alleen in de winkel verkrijgbaar, en dat lijkt me meer dan logisch. Het gaat om kaas, yoghurt, boter, vlees- en viswaren, en huisgemaakte sandwiches en salades. Ook handig om mee te nemen als middagmenu.
Dan blijft er nog genoeg over voor de webshop: producten uit bekende én minder bekende Franse regio’s, waar u als vakantieganger misschien fijne herinneringen aan heeft. Rob: „Bijna al onze klanten spreken Frans. In Den Haag en omgeving werken veel expats.”
Alle producten worden in Frankrijk ingekocht en zijn niet of nauwelijks in andere winkels te vinden. Rob vertelt enthousiast over zwarte knoflook, piment d’Espelette, truffelboter, fondant Baulois (chocolade met karamel en zeezout), foie gras en rillettes van vlees, eend en vis. En natuurlijk mogen de Franse wijnen niet ontbreken. „Vergeet ook de bijzondere Franse bieren niet. Fransen zijn er dol op, en ze zijn alleen bij ons verkrijgbaar.”
Les Belles Saveurs Breitnerlaan 14, Den Haag www.lesbellessaveurs.com







































































Bij het schoonmaken van witlof steekt Emmy Remmerswaal altijd een appelboor in de bodem om het harde gedeelte te verwijderen.







Willem Brouwer zoekt het oude, vertrouwde Oud-Hollandse snoep. „Bij Jamin en andere winkels zie je vooral winegums, maar ik wil gewoon drop.” Voor iets bijzonders moet de heer Brouwer eens kijken op eucalypta.nl. Een webwinkel die al een kwart eeuw bestaat en waar ook mijn drie favoriete snoepjes te krijgen zijn: groentjes, griotten en krijtjesdrop. Daarnaast vind je er laurierdrop, salmiak, jujubes én alle soorten winegums. Een paradijs voor een ouwe snoeper. En ja, daarmee bedoel ik mezelf.














een

Geor een s waar uit M zij kn met e ze er k kantor of n al n de en.
Snijbonen? Gewoon knippen!
Sni

George Hoogendoorn was op zoek naar een speciaal snijbonenmesje. Dat bestaat waarschijnlijk niet meer, maar Grieta Buitelaar uit Maasland heeft een praktische oplossing: zij knipt haar schoongewassen snijbonen gewoon met een keukenschaar. Ook rauwe kipfilet knipt ze ermee. Volgens haar veel voordeliger dan kant-en-klaar, en ook nog eens lekkerder. -en-klaar, en ook eens lekkerder.



U kent het begrip ‘vergeten groente’ vast wel. De meeste zijn volgens mij terecht vergeten omdat ze niet lekker zijn. Met pastinaak, koolrabi, aardperen, koolraap of knolraap doet u mij in elk geval geen plezier.

ns kker aardperen, u een














Klein jongetje







woonden. Maar toen ik op mijn twaalfde verhuisde naar de Utrechtse Heuvelrug, kende niemand het daar. En nu ik in de Betuwe woon, is het net zo onbekend. Dus moet ik het bestellen, of hopen dat de supermarkt het toevallig in het schap heeft liggen. Dit jaar heb ik het al zeven keer genuttigd, van de dinsdagmarkt in Rotterdam.
aladesofineen
Er is echter één groente die in sommige gebieden vergeten is of nauwelijks wordt gegeten en dat is postelein. Het heeft een frisse, licht zilte smaak en een knapperige bite. Ideaal in salades of in een stamppot. Dat laatste is bij ons het geval.



de Utrechtse kend ik ze d

Schoonspoelen
Sc Schoonspoele
Ik ben gek op de zomerpostelein. De wintervariant vind ik minder lekker. Ik at het als klein jongetje al, toen we in ’t Gooi


Ik prak de postelein het liefst met nieuwe aardappelen en een biefstukje, vanwege de lekkere jus. Vroeger moest je postelein eindeloos schoonspoelen vanwege al het zand, maar tegenwoordig komt het vaak uit de kas en zit er nog maar weinig aan.
Heeft u een geweldige tip of een leuk verhaal?

Mail naar info@emilebode.nl en maak kans op een waardebon van €25. Vergeet niet uw adresgegevens te vermelden.









































Augustus is gemaakt voor niksdoen. Niet een beetje niksdoen, maar écht niksdoen. Gewoon zitten in je oude tuinstoel (met dat ene wiebelpootje), voeten in een teil koud water, ijsje in de ene hand, vliegenmepper in de andere. De stokrozen leunen tegen de schutting alsof ze ook vakantie hebben. Je hebt al drie dagen niet naar de border gekeken, want waarom zou je? De bijen regelen het wel. De vlinders ook. Zelfs de mieren zijn op zomerreces. Voor de tuiniers onder ons betekent dat: even geen to-do’s. Geen lijstje met 23 taken en een deadline. Geen woeste opruimwoede met drie volle GFT-bakken of ‘morgen écht onkruid wieden’. En terwijl je hond uit de regenton staat te drinken, denk je: dit is het.Dit is vakantie in mijn eigen tuin. Er ligt ergens nog een zak potgrond, open sinds juni. Die mag best blijven liggen. Net als jij.


Niet
elke tuin in Nederland kan een tropisch regenwoud worden, maar een zonnig hoekje met een vleugje Caribische flair? Dat lukt wél. En nee, daar heb je echt geen zwembad of palmboom voor nodig. Begin met een plek in de volle zon, bij voorkeur tegen een warme muur of schutting. Zet daar een paar grote potten met bananenplant, oleander of knalroze fuchsia’s. Werk met kleur: denk turquoise stoelkussens, een knalgele parasol en een vrolijk tafelkleed. Zet tussen de planten een paar lavendelstruiken of rozemarijn voor een zomerse geur. Geen fan van felle kleuren? Kies dan voor een mix van rode agapanthus, oranje canna en donkerpaars sierblad.




2
1 N
Augustus kan heet en droog zijn. Zorg voor extra wateropvang als er dan eindelijk een bui komt.

Is je lavendel uitgebloeid? Knip hem licht terug voor een compacte struik én een tweede bloei.
3






Wil je kale plekken in de moestuin voorbereiden op volgend jaar? Strooi phacelia of klaver.












De zinnia is geen muurbloempje. Met haar felle kleuren, stevige stelen en recht-voor-z’nraap-uitstraling is het een bloem die zichzelf niet wegcijfert. En terecht: deze zomerklassieker hoort bij augustus zoals ijs bij hitte.
De bloemhoofden van de zinnia (Zinnia elegans) bestaan uit een vaste krans van bloembladen rond een geel hart. Van klassiek roze en vuurrood tot dieppaars en limoengroen: zinnia’s zijn er in alle kleuren. En hoe feller, hoe beter. Deze bloem is gemaakt om op te vallen in borders én in vazen.
vallen
zon, op een goed doorlatende, voedzame bodem. Regen of droogte? Geen probleem. Een beetje tuinder weet: hoe meer je snijdt, hoe meer ze bloeien. Zinnia’s zijn geboren snijbloemen. Pluk ze zodra de bloemblaadjes stevig aanvoelen en ze blijven tot wel tien dagen goed in een vaas. In bonte boeketten of juist solo, de zinnia brengt direct kleur en vrolijkheid in huis. Zinnia’s combineren mooi met zonnebloemen, siergras en cosmea, maar ook met planten met grijs of zilverkleurig blad, zoals salie of ezelsoor. Of kies voor één kleur en laat de bloei z’n werk doen.
Nachtvorst
Zinnia’s bloeien van juli tot in de nazomer en houden van warmte. Ze staan het liefst in de volle
uitstekend als eenjarige, mits ze een plekje krijgt waar de zon rijkelijk schijnt. Zaai je haar zelf? Dan bloeit ze soms zelfs tot de eerste nachtvorst.
De Azteken noemden de zinnia ooit mal de ojos ('pijn aan de ogen') vanwege haar felle kleuren. Vandaag de dag is die knalkleur juist haar grootste charme, vooral op een zonnig terras.

De zinnia komt oorspronkelijk uit Mexico en andere warme delen van Zuid-Amerika. Geen wonder dat ze zo goed tegen hitte kan. In Nederland doet ze het





















































































Kijk dan op

Twee gerechten voor dagen waarop het leven zich buiten afspeelt. De gazpacho is een ode aan eenvoud: rauwe groenten, koud geserveerd, vol smaak. Perfect voor wie liever een lepel dan een pan vasthoudt. De wraps met gehaktballetjes zijn zo’n klassieker die altijd werkt: hartig, fris en snel in elkaar gezet. Geen gedoe, wel gezellig aan tafel. Precies goed voor lange, lichte avonden.


Wrap met gehaktballetjes en yoghurt-knoflooksaus

✔ 8 wraps
✔ 400 g gehakt naar keuze
✔ 50 g roomboter
✔ Bosje lente-ui

✔ 2 blikjes tomatenblokjes (800 g)
✔ 1 bosje basilicum
✔ 2 tenen knoflook
✔ 1 komkommer
✔ 2 puntpaprika’s (uit blik)
✔
½ citroen
✔ Peper en zout


Bereiding voor vier personen
• Doe alle ingrediënten, behalve één blikje tomatenblokjes, in de blender en pureer tot een glad geheel.
• Voeg vervolgens het tweede blikje tomatenblokjes toe, zodat er wat grovere stukjes tomaat in de gazpacho blijven. Liever geen grote stukjes?

✔ 2 tenen knoflook
✔ Mespunt nootmuskaat
✔ 1 tl kerriepoeder
✔ 1 tl grove mosterd
✔ 1 el ketchup
✔ ½ ui
✔ 15 g peterselie

Voor de yoghurtknoflooksaus:
✔ 200 g Griekse yoghurt
✔ 2 tenen knoflook
✔ 1 tl sambal oelek
✔ 1 tl oregano
✔ Peper en zout
Bereiding voor vier personen
• Maal de knoflook, ui, peterselie, ketchup, mosterd, nootmuskaat en kerriepoeder met een staafmixer of in een keukenmachine zo fijn mogelijk.

• Breng op smaak met peper en zout en roer het sap van een
ueedabedebjestoatebojesdect mee met de rest van Breng smaak met peper en zout en roer het sap van een halve citroen erdoor
Pureer dan beide blikjes tomatenblokjes direct mee met de rest van de ingrediënten.


• in de koelkast en
Zet de soep tot gebruik in en serveer koud.



• Meng dit kruidenmengsel door het gehakt en breng op smaak met peper en zout. Draai er met de hand kleine balletjes van en braad ze in een koekenpan met de roomboter goudbruin.
• Voor de knoflooksaus: hak de tenen knoflook fijn en roer samen met de overige ingrediënten door de yoghurt.










soe verw S e g J to tom
• Smeer de wraps in met de knoflooksaus, leg er wat ijsbergsla op, gevolgd door een paar gehaktballetjes en wat fijngesneden lente-ui.

Je zou denken: vers is altijd beter. Maar bij tomaten klopt dat lang niet altijd. Ingeblikte tomaten worden pas geoogst als ze op hun lekkerst
zijn: v
zijn: vol smaak, sappig en mooi rood. Ideaal voor een soep als gazpacho. Je hoeft ze niet te snijden, geen schil te verwijderen: gewoon openen, gieten en klaar.








Portugal blijft een geliefde vakantiebestemming onder Nederlanders. Natuurlijk vanwege het weer, maar stiekem óók om de wijn. Vooral de frisse, licht sprankelende vinho verde is zeer gewild. Hoewel Portugal een klein land is, heeft het een enorme variatie aan microklimaten en bodems. Van de koele, groene heuvels in het noorden tot de warme, droge vlaktes in het zuiden; dat zorgt voor een grote diversiteit aan druiven en wijnstijlen. Die veelzijdigheid proef je terug. Dankzij de invloed van de Atlantische Oceaan ontstaan er frisse, lichte wijnen zoals vinho verde. Bovendien werkt Portugal vooral met eigen, inheemse druivenrassen die je bijna nergens anders ter wereld vindt, zoals Touriga Nacional, Trincadeira, Baga en Arinto. Dus probeer eens een Portugese wijn. En vergeet vooral de port niet. Niet alleen heerlijk bij een kaasplankje of als aperitief, maar ook heerlijk in een zomerse cocktail met tonic. Saúde (proost). 2



Licht mousserende witte wijn van de alvarinho-druif uit het noorden van Portugal. Laag in alcohol, fris en citrusachtig. Geweldig in de zomer en ideaal voor wie houdt van een levendige wijn zonder poespas.
LEKKER BIJ: Vis, salades of gewoon als borrelwijn.
Fluweelzachte, robijnrode wijn met een frisse en levendige stijl. Het bouquet is rijk aan aroma’s van rode vruchten zoals braam en kers. Elegant, soepel en met net dat beetje pit.
LEKKER BIJ: Hoe kan het ook anders: mediterrane gerechten.

DAVID VAN DEN BURG
Een dorstlesser voor warme dagen. Met munt, limoen en een scheutje roze port maak je in een handomdraai een frisse, zomerse mojito.

Stamp alles goed fijn met een muddler. 3

5

Doe 5 muntblaadjes, ½ limoen (in partjes) en 2 theelepels bruine suiker in een cocktailglas. 4
Schenk 5 cl Porto CRUZ Pink in het glas.

Vul aan met 10 cl bruisend water. 6

Voeg een flinke schep crushed ice toe. 1


Roer kort door, garneer met een schijfje limoen en een takje munt.






Vinho verde is top bij alles wat licht en gegrild is: kipspiesjes, garnalen, maiskolven. Die frisse zuren en zachte bubbels zorgen voor precies genoeg pit zonder te overheersen. Het is de wijn die je inschenkt als de zon nog net op het terras schijnt, de barbecue sist en je geen zin hebt in iets zwaars. Zelfs een simpele worst of stukje halloumi wordt er barbecue-waardig van.










‘Dirk is mijn geheime
Voor Christiaan Ridders (26) begint koken al in de supermarkt. Hij doet zijn boodschappen bij Dirk. Een bewuste keuze, want: „Daar vind ik precies wat ik nodig heb voor mijn kookavonden.”
Christiaan kookt het liefst Aziatisch. „Bij Dirk haal ik alles: van verse koriander tot goede noedels. Het is betaalbaar, vers en ik word er altijd vriendelijk geholpen.” Voor Christiaan is koken meer dan een hobby; het is zijn passie, zijn manier om liefde te tonen. „Ik hou ervan om uitgebreid voor mijn vriendin te koken. Dan trek ik er echt een avond voor uit om iets speciaals op tafel te zetten. Thaise curry, Japanse ramen, Vietnamese pho. Die geuren, smaken, die mix van kruiden en pit: daar kan ik echt in opgaan.”
Voordeel
Wat hij waardeert aan Dirk? De combinatie van versheid, aanbod en klantvriendelijkheid. De bekende Principes van Dirk sluiten naadloos
aan bij de wensen Christiaan. Onder andere: iedereen krijgt hetzelfde voordeel, er zijn geen dure spaaracties, boodschappen bezorgen is duur en je hoeft niet te hamsteren voor korting. „Soms ben ik op zoek naar iets wat niet standaard in het schap ligt, of juist naar een goede aanbieding, en dan is het fijn als ik dat hier ook echt vind. Ik wil graag koken met kwaliteit, maar ook efficiënt mijn boodschappen kunnen doen. Dat lukt hier.”
Christiaan droomt ervan om met een paar goede vrienden een eigen cateringbedrijf te beginnen. „We willen mensen laten proeven hoe lekker én toegankelijk goed eten kan zijn. Alles vers, vol smaak en met oog voor detail”, klinkt het. Voor Christiaan is het simpel: goed koken begint met goede ingrediënten. „En die haal ik bij Dirk. Ik weet dat ik bij Dirk terecht kan voor kwaliteit én inspiratie. Of ik nou voor twee of twintig mensen kook, ik loop altijd met een goed gevoel de winkel uit”, besluit hobbykok Christiaan. ■






































Je hebt vakantie, maar je hoeft je koffer maar één keer uit te pakken. Elke ochtend word je wakker op een nieuwe bestemming, terwijl je zelf nauwelijks in beweging bent geweest. Je dobbert van eiland naar eiland, en ondertussen wordt er voor je gekookt, opgeruimd en gezorgd. Klinkt goed? Wacht maar tot je de rest hoort.







Oo d
De zove z
Seascap ip: m schi

nze reis begon op Schiphol, met een vlucht naar Miami. We besloten daar één nachtje te blijven, vooral om even bij te komen van de reis en het tijdsverschil. De volgende ochtend was het zover: aan boord van de MSC Seascape. Een indrukwekkend schip: modern, luxe en zo groot dat het plek biedt aan 5.877 passagiers en 1.648 bemanningsleden. Wij hadden een hut met balkon én ligbedden; ik had me slechtere plekken kunnen voorstellen om de dag te beginnen..
Ongerept eiland
De eerste stop van onze cruise was Ocean Cay, een privé-eiland van MSC in de Bahama’s. Het is niet zomaar
een strandbestemming, maar een voormalige industriële zandwinningslocatie dat door MSC volledig is omgetoverd tot een duurzaam paradijs. De kenmerkende vuurtoren is het hart van het eiland en wordt ’s avonds sfeervol verlicht. Ocean Cay voelt als een plek waar je de tijd even vergeet. Hier draait alles om natuurbehoud en rust: geen grote beachclubs of rijen toeristen, maar een ongerept eiland met wuivende palmbomen, kristalhelder water en eindeloze witte zandstranden. Geen verkeer, geen drukte, alleen het geluid van de golven.
De dag erna legden we aan in Nassau, de hoofdstad van de Bahama’s. Felgekleurde koloniale huizen, levendige markten en street art: naast de prachtige stranden is er genoeg te zien en te beleven.
We boekten een excursie waarbij we langs de hoogtepunten van het eiland werden gebracht. We reden door charmante straatjes, stopten bij het Atlantis Resort op Paradise Island en eindigden bij John Watling’s Distillery. In een prachtig oud landhuis leerden we over het productieproces van traditionele Bahamaanse rum en natuurlijk mochten we ook proeven.
Na Nassau was het tijd voor een dag op zee. Aan boord van de MSC Seascape is dat allesbehalve saai. Het schip is zo groot dat je meerdere dagen nodig hebt om alles te kunnen zien. Er zijn zwembaden (waaronder zelfs een infinitypool), jacuzzi’s, spectaculaire glijbanen, een fitnessruimte, een theater en tientallen restaurants en cafés. Wij begonnen de dag met een luxe
brunch, brachten een bezoekje aan de spa en genoten van cocktails bij één van de zwembaden. De volgende ochtend kwamen we aan in Falmouth, Jamaica. Van daaruit gingen we met een excursie naar Ocho Rios, waar we begonnen met
Het schip is zo groot dat je meerdere dagen nodig hebt om alles te zien...


een rit in een kabelbaan bij Mystic Mountain die ons langzaam de jungle in bracht. Het uitzicht was werkelijk adembenemend, al raakten we lichtelijk in paniek van de enorme spinnen die in de bomen hingen. Zulke exemplaren hadden we nog nooit gezien.
Daarna bezochten we Dunn’s River Falls, de grootste waterval van Ocho Rios. Het is een van Jamaica's nationale schatten en echt een must see. Het bijzondere aan deze waterval is dat het uit verschillende plateaus bestaat. Heel Instagramwaardig, al moesten we wel opletten waar we liepen. En wanneer je naar Jamaica reist, ➜

























































































kan een ritje in een traditionele Jamaicaanse bobslee door de jungle natuurlijk niet ontbreken. Geïnspireerd op het beroemde olympische bobsleeteam raas je in een soort achtbaan naar beneden, dwars door het groen.
Kaaimaneilanden
Onze laatste stop was George Town op de Kaaimaneilanden. Wederom een pareltje: witte stranden, helderblauw water, en een gemoedelijke sfeer. De Kaaimaneilanden behoren tot de veiligste en welvarendste eilanden in het Carbisch gebied, en dat voel je meteen: alles is schoon, rustig en goed georganiseerd. Voor ons stond er een rum- en bierproeverij op de planning bij de lokale trots: de Cayman Spirits Company. De proeverij begon al om tien uur ’s ochtends, maar zoals ze daar zeggen: op de Kaaimaneilanden bestaat geen tijd. In plaats van een bescheiden slokje kregen we








is goed toeven op de Kaaimaneilanden.



De voordelen van een cruise? Je ziet veel zonder het ‘reis-ongemak’
een glas in onze handen gedrukt met de boodschap: ‘Drink as much as you like.’ En dat deden we.
Na de proeverij genoten we van de prachtige stranden en azuurblauwe zee. Overvolle stranden en beach-
club ni g z C N op we o Miami een volle d lb
clubs vind je hier niet gewoon puur genieten van zon, zand en de ontspannen Caribische vibes. Na een laatste dag op zee meerden we opnieuw aan in Miami, waar we nog een volle dag hadden voor onze terugvlucht. We maakten er goed gebruik van: naar South Beach, Bayside Marketplace, Little Havana en vervolgens een rit naar de Everglades. Daar maakten we een tocht met een airboat door het moeras, op zoek naar alligators. Van een veilige afstand, gelukkig.
Wat deze reis zo bijzonder maakte, was de afwisseling. Van rustige stranddagen tot actieve excursies, van indrukwekkende natuur tot lokale proeverijen. En dat alles zonder steeds opnieuw je koffer te hoeven pakken. Een cruise is wat dat betreft echt ideaal: je ziet veel in korte tijd, maar met het comfort van een vaste plek. En het mooiste van alles? Terwijl je ’s nachts slaapt, vaart het schip gewoon rustig door naar de volgende bestemming. Wij hebben aan boord al stiekem naar de volgende route gekeken. ■







Nieuw: Appelsientje FruitDrink. Een heerlijke fruitdrink met fruit, water en een vleugje zuivel voor een volle fruitige smaak. Ontzettend lekker, met minder suiker én extra aantrekkelijk geprijsd! Appelsientje FruitDrink, een gezonde en slimme keuze voor elk moment van de dag!







Elske en Niels vielen in 2022 als een blok voor Les Issambres aan de Côte d’Azur: azuurblauwe zee, groene heuvels en een mild klimaat. Ze bouwden er hun eigen droomplek: villa Oliveira, mét lokale wijn om de hoek, patisserieën in de buurt en genoeg fijne restaurants.
Elske en Niels vonden hun luxe Provençaalse villa drie jaar geleden via een gouden tip van een vriend die al twintig jaar een vakantiehuis in deze streek heeft. Oliveira ligt op tweehonderd meter hoogte op een idyllische plek, met uitzicht op de glooiende heuvels en de baai van Saint-Tropez. „Overdag is er volop zon op de verschillende terrassen en ’s avonds is de zonsondergang elke keer weer betoverend”, zegt Elske.
Jantine: „Prachtig huis. Lekker ruim.
Complete keuken. Heerlijke buitenruimte met acht ligbedden. We hebben vooral veel genoten van het zwembad!”
Direct achter Oliveira starten verschillende wandelroutes door een prachtig natuurgebied. Met de Bateaux Verts vaar
je vanuit de haven van Les Issambres zó naar Saint-Tropez, bijvoorbeeld voor de bekende dinsdagmarkt. „Dankzij de centrale ligging zijn alle bekende plekken aan de Côte d’Azur gemakkelijk bereikbaar met de auto: Cannes, Antibes, Nice of Aix-en-Provence”, vertelt Niels. In 2022 en 2023 werd Oliveira volledig gerenoveerd, met vijf slaapkamers en drie badkamers als resultaat. Niels verzorgde de herindeling, met als uitgangspunt: optimaal uitzicht en directe toegang tot het zonneterras en het verwarmde zwembad via royale glazen schuifpuien.
Elske struinde zowel in Nederland als Frankrijk onvermoeibaar naar de juiste meubels en accessoires om in villa Oliveira een warme, fijne sfeer te creëren. Sinds de zomer van 2023 staat Oliveira op Micazu en dat loopt vlekkeloos. De recensies zijn lovend. Elske wordt vooral heel erg blij van warme woorden in het gastenboek over ‘haar’ inrichting. ■

Les Issambres Les (Côte d ’Azur) d’Azur) FRANKRIJK

GESCHIKT VOOR 2-8 personen
BOEKEN Geen boekingskosten en direct contact met Elske & Niels.
BEOORDELING 8,7
MEER INFO? Scan de QR-code

OOK JOUW VAKANTIEHUIS VERHUREN? Begin met verhuren en ontwerp vrijblijvend je advertentie op Micazu.nl


Kunst, cultuur en… natuur! Bezoek een van deze inspirerende cultuurtips, of zoek het hoger op: in een van deze top 5 uitkijkpunten!

Een weekendje weg in Nederland, maar geen zin om het zelf te regelen? Laat het dan lekker uit handen nemen. Jij kiest een pakket, vult een korte vragenlijst in, en daarna kun je weer doen waar jij zin in hebt. Verrassend op Stap regelt jouw overnachting inclusief ontbijt, reserveert een tafel bij een restaurant dat past bij jouw wensen én organiseert een verrassende activiteit. verrassendopstap.nl
Museum de Fundatie brengt deze zomer het Nederlands impressionisme tot leven. Van Israels tot Ansingh én Van Gogh, Mondriaan en Daubigny; alles komt voorbij in een warme, sfeervolle ode aan licht, kleur en penseel. ‘Nederlands impressionisme’ is te zien t/m 17 augustus.

Zand tussen je tenen en de stem van Ali Campbell in je oren: UB40 komt naar Scheveningen! Op 3 september trakteert de legendarische Britse band het strandpubliek op een tropisch concert vol hits als Red Red Wine Een zwoele nazomeravond gegarandeerd.

Vincent van Gogh, De molen ‘Le blute-fin’ (1886).



De Delftse Muziek & Theater Parade trekt op 13 september feestelijk door de binnenstad. Meer dan twintig orkesten en straattheateracts zetten de stad op z’n kop, met een finale op de Markt. Dit is de allerlaatste editie van deze ode aan Taptoe Delft. Mis ’m niet!
Tien zwoele avonden vol locatietheater in het Amsterdamse Bos: ‘Bosfest’ is terug! Van 20 t/m 30 augustus vormt het ritselende bladerdak het decor voor verrassende performances en theatrale sferen. Verdwaal in het bos én het verhaal.

In ‘Aan de andere kant van de oceaan’ toont SCHUNCK Museum in Heerlen hoe kunst de brug slaat tussen Curaçao en Limburg. Met werk van Rinella Alfonso en Charles Eyck, plus jonge makers onder leiding van Raenys Martis. Het toont de verschillen tussen het Curaçao van nu en toen en stipt thema’s als identiteit en erfgoed aan. Open tot en met 14 september.








1
UITKIJKTOREN POMPEJUS, BERGEN OP ZOOM
Deze uitkijktoren is 24/7 gratis toegankelijk en biedt een prachtig uitzicht over de omgeving.
2
Deze houten uitkijktoren op de Holterberg is vrij toegankelijk en biedt uitzicht over de heidevelden.
De iconische Euromast is dagelijks geopend van 09.30 tot 23.00 uur. Bezoekers kunnen genieten van het uitzicht vanaf de platforms en de Euroscoop (tegen meerprijs).
4
Deze toren biedt een panoramisch uitzicht over het natuurgebied De Onlanden. Het is een uitstekende plek om vogels te spotten.
De vuurtoren is op wisselende dagen geopend, kijk op de website voor openingstijden en prijzen. Bij helder weer zijn omliggende eilanden en de kust zichtbaar.

Toen de Franse kunstenaar







Wie kent haar niet? De ballerina van de Franse Edgar Degas is een icoon. Gemaakt in de negentiende eeuw, maar je kunt haar vandaag de dag zomaar tegenkomen in een modeblad of op de rode loper. Als jong meisje vond ik haar prachtig. Zo elegant en talentvol wilde ik ook zijn, stralend op een podium. Jaren later ontdekte ik het pijnlijke verhaal achter de ballerina. In het Parijs van toen werden meisjes, vaak uit arme gezinnen, getraind om op te treden. Rijke mannen maakten hen financieel afhankelijk, wat tot allerlei vormen van uitbuiting leidde. Een van mijn favoriete kunstenaars, de Britse Ryan Gander, laat zich door Degas’ danseres inspireren. In Museum Beelden aan Zee in Scheveningen toont hij haar, bevrijd van haar barre omstandigheden en bevrijd van haar podium. Ze is een meisje zoals ze had moeten zijn, met onzekerheden, verlangens en dromen.
Sietske van Zanten is directeur van het LAM, gewoon een bijzonder museum. In het LAM, midden in het groen van Landgoed Keukenhof in Lisse, ga je bijzonder kijken naar heel gewone dingen. Volg het museum op Instagram via @lam_museum, of bezoek lammuseum.nl.

Edgar Degas (18341917) zijn beeld Petite Danseuse de Quatorze Ans rond 1880 voor het eerst tentoonstelde in Parijs, veroorzaakte dit een schok. Zijn beeld was veel realistischer dan de mensen gewend waren. De ballerina was gekleed in een stoffen tutu, droeg balletschoenen en een pruik van echt haar. Het publiek vond haar lelijk. FOTO : VET H

Parijs, veroorzaakte dit een schok. beeld was dan de mensen waren. De was in een en een van echt haar. Het vond haar



























MARIE VAN GOETHEM WAS MODEL VOOR HET BEROEMDE BRONZEN BEELD VAN DEGAS. MARIE KWAM UIT EEN ARME, VLAAMSE FAMILIE EN DANSTE AL JONG BIJ DE PARIJSE OPÉRA.



















































PetiteDanseusedeQuatorzeAns(1880) door Edgar Degas.







Ryan Gander (1976) is een beroemde Britse kunstenaar die vaak humor gebruikt om je te raken. In het LAM museum hebben we een video van hem. Het kunstwerk lijkt een gelikt reclamespotje. Alleen verkoopt hij geen product of dienst, maar iets essentieels dat iedereen gratis bij zichzelf kan oproepen: verbeelding.
Edgar Degas verbeeldde nog veel meer ballerina’s in brons en in verf. Zijn danseressen laten niet het perfecte plaatje zien. Ze zijn moe, buigen, krabben, en rekken zich uit.
In het fraaie Museum Beelden aan Zee zie je tot en met 4 januari 2026 een echte bronzen danseres van Edgar Degas uit Museum Boijmans Van Beuningen, omringd door 21 versies van haarzelf, gemaakt door de hedendaagse kunstenaar Ryan Gander. Het is de eerste solotentoonstelling van Ryan Gander in Nederland.

Youwalkintoaspace,anyspace, of, Poorlittlegirlbeatenby thegame(2010) door Ryan Gander.

MET DE BRONZEN BEELDEN VAN RYAN GANDER
LIJKT HET ALSOF DE BALLERINA NA EEN DOORNROOSJESLAAP WAKKER IS GEWORDEN IN HET NU. ZE HOEFT NIET MEER OP TE TREDEN, MAAR KAN ZIJN ZOALS ALLE MEISJES VAN VEERTIEN. SOMS SPEELT ZE, SOMS VERVEELT ZE ZICH, SOMS SLAAPT ZE EN SOMS IS ZE REBELS.
Net als de veertienjarige danseres krijgen alle kinderen tot en met veertien jaar gratis toegang tot de tentoonstelling in Museum Beelden aan Zee. Ryan Gander: „Jongeren interpreteren kunst eerlijk – ze zeggen dingen die volwassenen misschien niet durven te zeggen omdat het te voor de hand liggend lijkt.”
UITJE MUSEUM BEELDEN AAN ZEE LIGT DIRECT AAN DE DUINEN. TIP: COMBINEER DE BEELDEN MET EEN DAGJE STRAND!
De ballerina’s van Degas vind je niet alleen in musea, maar ook op de rode loper. Kijk maar naar de Amerikaanse zangeres Chappell Roan tijdens de Grammy Awards. Ze draagt hier een jurk van Jean Paul Gaultier, geïnspireerd op Degas’ schilderij Dancer with a Bouquet

gas vind je maar ook maar naar eres ns de hier l Gaultier, s’ et




































Ze ziet eruit alsof ze net van school komt (is ook zo), maar trapte zich al twee keer naar de wereldtop. Thaibokser Cheyenne Aldus (18) uit Capelle aan den IJssel, ook wel bekend als The Destroyer, weet precies waar ze voor gaat: trappen, winnen, respect afdwingen. Wij stellen Cheyenne de zeven vragen.
1
Vanwaardie bijnaam, TheDestroyer?
„Een trainer liet ooit een roze pakje voor me maken met ‘The Destroyer’ erop. Sindsdien ben ik dat gewoon. Grappig, want ik was vroeger onzeker. Als iemand me aanraakte, begon ik al te huilen. Buiten de ring ben ik heel anders dan in de ring. In de ring gaat er een knop om. Dan denk ik gewoon: ik ga je slaan. Maar als er op straat ruzie is, loop ik liever weg.”
2
InRotterdamzeggen
ze: geenwoorden maar daden.Is dat ookjouwmentaliteit?
„Ja!Tegenstanders praten vooraf superveel: dat ik te jong ben, dat ik ga verliezen, bla bla bla. Maar ik hou liever m’n mond en laat in de ring zien wat ik waard ben. Mensen onderschatten me vaak. Laatst nog, een meisje hoorde dat ik tweevoudig wereldkampioen was en zei: Maar ze ziet er helemaal niet gevaarlijk uit.”
3
Wanneerwistje: ditismijnsport?
„Mijn ouders hebben een kickboksschool, maar ze wilden nooit dat ik ging vechten. Ze vond het een mannensport. Tot er een keer een meisje binnen-
kwam dat door tien jongens in elkaar was geslagen. Toen zeiden ze: oké, je mag trainen. Maar geen wedstrijden. Inmiddels heb ik 141 partijen gevochten en mijn moeder heeft er niet één gemist. Ze zegt altijd: als het begint, voelt het alsof mijn keel wordt dichtgeknepen. Pas als m’n hand omhooggaat, het teken dat ik heb gewonnen, valt alles van haar af.”
4
Hebjeookeenback-up plannaastdering?
„Ja, ik heb net m’n CIOS-diploma gehaald, een sportopleiding voor trainers en coaches. Van alleen vechten kun je als vrouw niet leven. Alleen zwaargewichten zoals Rico Verhoeven verdienen echt geld, maar GLORY Kickboxing heeft de hele vrouwendivisie geschrapt. Terwijl er juist steeds meer meiden gaan kickboksen. De wereld wordt gekker en harder, meiden willen zich sterk voelen.”
5
Wordjijstraksde vrouwelijkeRico?
„Zeker niet. Iedereen buiten de sport vindt hem geweldig, maar in dit wereldje vinden wij hem eigenlijk best saai. Hij tikt vooral punten bij elkaar, blijft op afstand.
Dat is niet spannend. Ik zou het interessanter vinden als hij gewoon een keer écht voor een knock-out gaat. Ik ben zelf een technische vechter, maar ik wil ook het publiek vermaken.”
6
Brengjeoffers?
„Voor een partij moet ik soms flink afvallen. Laatst moest ik een paar kilo droppen terwijl m’n vader zijn verjaardag vierde in een all you can eat-restaurant. Ik bleef thuis. Want anders moet je daarna keihard knallen om op gewicht te komen. En als je dat niet haalt, mag je niet vechten.”
7
Watdrijftjou?
„Kickboksen is m’n uitlaatklep. Alles wat je meemaakt op school of online, haatreacties en zo, ik laat het allemaal los in de ring. Bovendien maak ik m’n familie trots, dat vind ik nog het mooiste. Ik wil nog veel wereldtitels winnen. Ik heb er nu twee als prof, in 55 en 57 kilo. Mijn grote droom is wereldkampioen te worden bij ONE Championship in Azië. Daar is kickboksen echt supergroot. Als je daar wint, behandelen ze je als een koning of koningin.” ■


'De wereld wordt harder, meiden willen zich sterk voelen'











Geen zonnebrillen, geen sportwagens, geen opschepperij. De man achter
Blikkendag, de grootste meezinger van het jaar, rijdt in een Volkswagen en drinkt thee voor z’n stembanden. „Ik wil gewoon zingen”, zegt Sven Versteeg. En dus werkt hij. Keihard.
on g
Stel je voor: vierhonderd optredens in twaalf maanden. Dat is bijna élke dag op pad, met nauwelijks tijd om adem te halen.
en




Sven Versteeg (28), de volkszanger achter Blikkendag en Heb lak aan wat ze zeggen, draait inmiddels op discipline en adrenaline. „Ik zeg eerlijk: het is pittig”, zegt hij zonder omhaal. „Zo’n jaar als dit doe ik nooit meer. Maar ik klaag niet, dit is waar ik altijd voor gevochten heb. Dus ik let op alles: geen drank, geen onnodige prikkels.



„ ZOVEEL AANDACHT , DAAR
JE WEL
WENNEN” dr d ank, k geen onnoodi d
s Wa

Ik bewaar m’n kracht voor dat ene moment, daar op het podium. Want dat is waar ik leef.”
Sven: ,,Vroeger maakte ik sfeer. Nu komen ze voor míj.”
die gewoon wat liedjes komt zingen. Alleen ja, overal waar ik kom, gaat het los. En dan zit je even later weer alleen in de auto. Dat contrast blijft lastig.”
Op z’n kop
Ment Blikken doorrbra „Vroege voorrdeu aa a n de d kan da be d
Blikkendag was zijn grote doorbraak. Dat veranderde alles. „Vroeger liep ik gewoon via de voordeur naar binnen, colaatje aan de bar, en zingen maar. Nu kan dat niet meer anoniem, dat blijft gek”, zegt hij. ,,Ik ben zelf niet veranderd, denk ik. Maar mentaal is het pittiger. Zoveel aandacht, daar moet je aan wennen. Terwijl ik nog steeds die gast ben
Al acht jaar stond Sven op het podium, met nummers die het 'best oké' deden in het Nederlandstalige circuit. Maar Blikkendag voelde anders. „Ik wist: dit zet alles op z’n kop.” De rest is hitgeschiedenis. Vier maanden in de Single Top 100. Op repeat in voetbalkantines, feesttenten en op TikTok. De opvolger Heb lak aan wat ze zeggen, geschreven door Yves Berendse, lag al klaar. Sven had zijn moment geroken. En hij beet zich erin vast.
Een droom
Het wereldje van de volkszangers is groot. Iedereen kent wel iemand d l d k























met een microfoon en een droom. Dus hoe zorg je dat juist jouw stem blijft hangen? „Je hebt mazzel nodig”, zegt Sven. „En de gunfactor. Maar het belangrijkste is toewijding.” En dan is er nog die ene factor die je niet kunt afdwingen: de hit. „Hij hoeft maar één keer te vallen. Dan heb je naamsbekendheid, en daar heb je jaren profijt van.” Toeval? Daar gelooft Sven niet in. „Mijn motto is: je laatste optreden moet je beste zijn. Want als je indruk maakt, word je teruggevraagd.”

gelukkig. Wat wil een mens nog meer?”
„Het verliezen van mijn stem is mijn grootste angst”, vervolg Sven. „Het is zo’n kwetsbare spier. Ik ben er non-stop mee bezig: thee, stomen, opwarmen, kalm blijven.”
Toch ging
➜

Wie denkt dat een gouden plaat automatisch leidt tot een optrekje met oprijlaan, komt bij Sven bedrogen uit. Hij woont in Diemen, met vriendin Daisy, dochter Jaidy, labrador Dex en hij rijdt in een Volkswagen Tiguan. „Comfortabel voor de lange ritten.” Droomt hij van een villa, zoals collega-artiesten?
„Nee joh, zover ben ik nog lang niet.” Hypotheek krijgen als zanger is al lastig genoeg. „Je bent zzp’er in een kwetsbaar vak. Als m’n stem ermee kapt, is het klaar. Daar houden banken niet van.” Klokkies en snelle wagens hoeft hij niet. „We wonen mooi, ik heb een gezin, we zijn












































































































het onlangs mis. Voor het eerst in zijn carrière moest hij optredens afzeggen omdat zijn stem het niet meer deed. „Ik zat gelijk bij mijn KNO-arts, Dennis Kox. Ik dacht: dit komt nooit meer goed. Maar hij stelde me gerust, het was gewoon overbelasting. Na twee dagen was mijn stem er weer, maar je schrikt je rot.”
Thuis is Sven geen artiest, maar vader. Zijn vriendin Daisy gaf haar baan op om fulltime voor hun dochter te zorgen. „Als zij niet zoveel liefde en energie in die kleine zou stoppen, had ik mijn carriere niet op deze manier kunnen ontwikkelen.” Zijn stem verzacht: „Het vaderschap vind ik het mooiste wat er is. Ik hoef ’s ochtends niet om zeven uur naar kantoor, dus die ochtenden zijn echt van mij. Met haar. Dat is top. Maar het is ook veel missen.”
Geluidsman
Sven begon niet als zanger, maar achter de schermen „Vanaf jongs
af aan wist ik: ik word de beste geluidsman van Nederland”, vertelt hij. Vanaf zijn twaalfde werkte Sven elk weekend bij een geluidsbedrijf, vaak tot diep in de nacht. Op mijn 21ste deed ik besloot ik een jaar vol
„
voor het zingen te gaan.” Zijn opleiding? Café Bolle Jan op het Rembrandtplein. „Ik stond daar drie jaar lang, twee keer per week. Van negen uur ’s avonds tot vier uur ’s nachts. Een half uur zingen, een half uur pauze.”
Zijn naam siert inmiddels de affiches van feesttenten en zalen als AFAS Live, maar Sven zelf is opvallend onaangedaan. „Concurrentie? Die voel ik niet. Ik ben met iedereen oké.
Het gaat erom dat je opvalt, dat mensen je willen boeken. Ik doe dat door mezelf te zijn. Ik speel geen typetje. Wat je ziet, is wat je krijgt. Ik wil mensen vermaken, ik hoef niet de beste zanger van Nederland zijn.”
Sven kijkt op naar Jan Smit, Jeroen van der Boom en Marco Borsato. „Doodzonde dat we zijn liedjes bijna niet meer horen.”
En dan rijst de vraag: wat doe je als je op je 28ste alles hebt bereikt waarvan je dacht dat het niet voor jou was weggelegd? „Ik heb een Top 40-hit gehad, op grote podia gestaan, miljoenen streams...
Ik had daar nooit van durven dromen, omdat het onbereikbaar leek. Maar het is gelukt en dat neemt niemand me meer af. Ik kan mijn leven lang zeggen: ik had een hit. Een grote! Het enige wat ik nu nog wil is vooral blijven zingen. Nog zeker twintig, dertig
ttenten en aar Sven zelf angedaan. ie voel ik niet. en ik had een hit. E wil is vooral zingen. Nog dert jaar.”







Sven: ,,Voor nu geen bruiloft, wél een volle agenda en onze dochter."


De Amsterdamse Zomer met René en Didier Froger.








Je kent Sabrina Carpenter misschien van Espresso. Of van die nu al beruchte albumhoes van Man’s Best Friend, waarop ze als een sexy 'schoothondje' op handen en knieën zit voor een man. Na bakken kritiek volgde er een nieuwe cover: zwart-wit, hoofd op zijn schouder en ‘goedgekeurd door God’.


Wie Sabrina live ziet, krijgt geen brave popshow. Inmiddels berucht onder fans: bij elk optreden beeldt ze een ander seksstandje uit. In Parijs was het de Eiffeltoren, in Amsterdam koos ze, hoe kan het ook anders, de fietspositie.









2014: Doorbraak als Disney-actrice in Girl Meets World
2021: Ze scoort haar eerste grote hit met Skin
2022: Persoonlijk album Emails I Can’t Send krijgt lof
2023: Videoclip Feather zorgt voor een rel in de Katholieke Kerk






2024: Support act in Taylor Swifts Eras Tour + debuut op Coachella


2025: Ze wint twee Grammy’s


2024: Wereldhits Espresso (#3) en Please Please Please(#1)

2024: Album Short n’ Sweet op #1 in Billboard 200, platina in een maand
2025: Aankondiging van nieuw album Man’s Best Friend, release 29 augustus


2024: Eerste vrouw met drie gelijktijdige top 10-hits in de Hot 100
























NAAM: Sabrina Annlynn Carpenter
GEBOREN: 11 mei 1999, Quakertown (Pennsylvania, VS)
OPLEIDING: zangopleiding,Thuisonderwijs, Disney Academy

GEZIN: Groeide op met drie zussen en een vader die haar thuisstudio bouwde
RELATIESTATUS: Had een knipperlichtrelatie met Barry Keoghan, maar ze is momenteel single

GESCHAT VERMOGEN: €11 miljoen (CelebrityNetWorth)



Sabrina komt uit een creatief nest. Haar moeder was danseres, haar vader speelde in een band en haar tante spreekt Bart Simpson in. Zelf begon ze als tiener op YouTube met Christina Aguilera-covers in een paarse kelderstudio, gebouwd door haar vader. Op haar dertiende verhuisde ze naar L.A. en werd ze een Disney-ster. Drie seizoenen lang was ze Maya Hart in Girl Meets World. Braaf, netjes, vlecht in het haar.

„Sabrina speelt met vuur, en dat maakt haar zo onweerstaanbaar, maar niet iedereen kan die hitte aan.”


„Ik hou van de gezichten van de jaren 60 en 90. Het oude Hollywood, flirterig en leuk.”




„Niet om de persoon te zijn die zijn astrologie erbij haalt, maar ik ben een Stier. Sommige mensen noemen dat koppig. Ik noem het: gedreven.”



„Dit beeld zet vrouwen decennia terug. Ze is gereduceerd tot huisdier, accessoire en object.”
MUZIEKPRODUCENT PETE WATERMAN:
„Als je vraagt om respect, treedt dan niet op in een string.”

„Vrouwelijke artiesten zijn altijd al beschimpt. In de ‘noughties’ was het Rihanna, in de ‘nineties’ was het Britney Spears, in de ‘eighties’ Madonna. En nu ben ik het.” z In R w in


SINGER-SONGWRITER CARLY SIMON:

„Concerten zonder telefoon zijn zo mooi.” j MAN :



„Ze doet niets schandaligs. Het lijkt tam. Er zijn veel opvallender platenhoezen geweest dan die van haar. Dus ik snap niet waarom zij zo veel kritiek krijgt.”


n meende het d’ d’. Of aan? et en














In 2021 brak Olivia Rodrigo door met Drivers License, een gebroken-hart-hit over haar ex Joshua Bassett. Fans speculeerden dat Joshua Sabrina had ingeruild voor Olivia… of andersom. Sabrina reageerde met haar eigen nummer Skin, waarin ze zingt: ‘Misschien meende je het niet, misschien was ‘blond’ gewoon het enige rijmwoord het écht zo is gegaan? Geen idee. Maar het leverde wel drie popcarrières én een hoop TikToks op.











































Heerlijke snack met 95% vlees
Zonder toegevoegde suikers
Zonder kunstmatige kleurstoffen
Zonder kunstmatige smaakversterkers
Makkelijk in stukjes te breken




















































































Angela Schijf blaast op 3 augustus 46 kaarsjes uit. Taart op de set, applaus van de crew, maar dit jaar geen felicitatie-selfie met ex-Flikken-Maastricht-collega Victor Reinier.
Flikken Maastricht is al jaren een kijkcijferkanon, met Angela Schijf en Victor Reinier als het dynamische duo Eva en Floris. Maar na negentien jaar liep het opeens helemaal mis. Begin dit jaar werd Reinier, die niet alleen acteerde maar ook regisseerde, de laan uitgestuurd. Officieel vanwege ‘de werksfeer’. Officieuzer: omdat hij zich achter de schermen grensoverschrijdend zou hebben gedragen. Volgens de wandelgangen –van juicekanaal tot Vlaamse krant – was Angela zélf het mikpunt van Reiniers uitbarstingen. Een aanvaring over een script liep zo hoog op dat de actrice overstuur de set zou hebben verlaten.

En dan die hardnekkige roddel: dat ze een blindedarmontsteking zou hebben gefaket om onder een aflevering van Victor uit te komen. Juicy? Zeker. Waar? Niemand weet het. Maar Victor is weg. Angela bleef. In een Instagrampost schrijft ze fijntjes: ‘Veel is anders, maar gelukkig ook veel hetzelfde.’Met andere woorden: Flikken (seizoen 20) draait weer, maar zonder de man die jarenlang naast haar stond. Feest? Zeker. Maar met de slingers strak gespannen.
naast haar stond Feest? ra a t . ak gespannen.
nog meer






















NICOLETTE VAN DAM actrice/presentatrice 14 augustus, 41 jaar
HARM EDENS presentator 4 augustus, 64 jaar







ROBIN VAN PERSIE trainer Feyenoord 6 augustus, 42 jaar



HÉLÈNE HENDRIKS presentatrice 6 augustus, 45 jaar





LOUIS VAN GAAL oud-bondscoach 8 augustus, 74 jaar


door Savanna Bosch
MAAGD 23 augustus - 23 september
Augustus vraagt je niet alles te analyseren. Laat je leiden door je gevoel. In de liefde komt geluk als je spontaner bent. Durf je hart te volgen, zelfs als dat onlogisch lijkt. Een onverwachte ontmoeting kan je wereld veranderen. In relaties draait het om acceptatie. Niemand is perfect, jij ook niet, Maagd. Dat besef opent de deur naar echte verbinding.
WEEGSCHAAL 24 september - 23 oktober
Balans in de liefde staat centraal. Heb je teveel gegeven? Augustus helpt je evenwicht te vinden. Singles ontmoeten iemand met wie alles lijkt te kloppen. In een relatie draait het om samenspel en harmonie. Geluk zit in het samen lachen, samen dromen. Laat verwachtingen los en leef in het moment. Echte liefde groeit stilletjes, geef het de ruimte.
SCHORPIOEN 24 oktober - 22 november
Jouw intensiteit trekt deze maand diepe, zielsverwante connecties aan. Je voelt snel of iets echt is. Durf daar op te vertrouwen. Liefde vraagt om openheid, hoe spannend ook. Geluk komt wanneer je de controle loslaat en het leven je laat verrassen. In relaties is eerlijkheid nu belangrijker dan passie. Laat je hart spreken, zelfs als je stem trilt. Wees niet bang om je donkere kant te laten zien; dat maakt je juist menselijk. Wie jou echt wil, blijft ook als het even stormt.
BOOGSCHUTTER 23 november - 21 december
Augustus brengt een frisse wind in de liefde. Flirts zijn luchtig, maar kunnen onverwacht dieper gaan. Geluk ligt buiten je comfortzone. Maak een spontane trip of zeg ja tegen een blind date. In relaties zorgt humor voor hernieuwde aantrekkingskracht. Deel je dromen, je partner luistert écht. Vergeet niet: liefde hoeft niet ingewikkeld te zijn. Geniet. Lach. Leef.
STEENBOK 22 december - 20 januari
Je hartenwens lijkt binnen bereik. Maar eerst moet je (weer) durven voelen. Liefde vraagt deze maand om zachtheid. Laat je muren zakken, laat iemand dichtbij. Geluk vind je niet in controle, maar in overgave. Zit je in een relatie? Herken elkaars inzet – en toon waardering. Singles vinden liefde waar ze het minst zoeken. Volg niet het plan, maar volg je gevoel, Steenbok.
WATERMAN 21 januari - 19 februari
Liefde verrast je deze maand, iemand begrijpt je onvoorspelbare aard én bewondert die. Augustus is gunstig voor flirts die uitgroeien tot iets serieus. In een relatie? Experimenteer samen, breek uit de sleur. Geluk komt uit verbinding zonder verplichting. Laat je hart spreken zonder angst. Onverwachte ontmoetingen geven je vlinders. Verzet je niet. Dit kan wel eens echt zijn.
23 juli - 22 augustus
Verjaardagsmaand? Dan straal je extra. Je aantrekkingskracht is onweerstaanbaar en liefde volgt vanzelf. Iemand bewondert je kracht én je kwetsbaarheid. Geluk komt als je je trots even opzij zet en eerlijk durft te zijn over je gevoelens. In een relatie? Samen plannen maken brengt verdieping. Laat complimenten toe. Accepteer liefde in alle vormen, het maakt je sterker.
VISSEN 20 februari - 20 maart
Je romantische ziel bloeit op, Vissen. Augustus schenkt tedere momenten, diepgaande gesprekken en zielsconnecties. Singles kunnen een karmische liefde ontmoeten. In een relatie voel je je gehoord en gezien, als je durft te delen. Geluk zit in kwetsbaarheid. Laat je dromen niet alleen in je hoofd bestaan, spreek ze uit. Liefde is dichterbij dan je denkt.
RAM 21 maart - 20 april
Augustus brengt vurige ontmoetingen. Singles krijgen onverwachte aandacht van iemand met lef. In relaties laait de passie opnieuw op, mits je de controle loslaat. Een spontane reis of verrassend gebaar zorgt voor geluk. Vertrouw op je intuïtie, niet op wat anderen vinden. Lach vaker. Wat je uitstraalt, trek je aan, Ram. Laat liefde je leiden. De rest volgt dan vanzelf.
STIER 21 april - 21 mei
Je stabiele aard trekt deze maand een loyale partner aan of verdiept je bestaande relatie, Stier. Verwacht romantiek tijdens een etentje of tijdens een wandeling in de natuur. Geluk ligt in kleine gebaren: een knuffel, een liefdevolle blik. Heb vertrouwen: durf je hart open te stellen, Stier. Ruzies verdwijnen als sneeuw voor de zon zodra jij kiest voor zachtheid. Geniet ervan!
TWEELINGEN 22 mei - 21 juni
Liefde bloeit op uit een goed gesprek. Iemand begrijpt je écht en dat voelt magisch. Flirtjes kunnen zomaar iets serieus worden, Tweelingen. In relaties keert de speelsheid terug. Ga samen iets nieuws doen, dat brengt geluk. Augustus vraagt je keuzes te maken. Geef toe aan wat je voelt. Humor opent harten, gebruik het. Laat de kans op echte liefde niet glippen.
KREEFT 22 juni - 22 juli
Je hebt de neiging je hart te beschermen, maar deze periode daagt je uit om het open te stellen. Iemand wil écht dichtbij komen. Laat dat toe, zelfs als het spannend voelt. Liefde en geluk zitten nu niet in perfectie, maar in kwetsbaarheid. Een warme blik of oprecht gesprek kan je hart sneller doen kloppen, Kreeft. Plan quality time. Vertrouw: wat jij geeft, komt deze maand dubbel en dwars terug. Dus geef gul!










Schaam je er niet voor, stel je vraag aan Lieve. Ze helpt je! lieve@dend.nl.
Hoi Lieve, Mijn vriendin zegt altijd dat haar telefoon op stil staat. Maar laatst trilde hij midden in de nacht, en toen ik keek, stond er: 'Nieuwe match!'. Ze lachte wat zenuwachtig toen ze wakker werd en zei dat het om een oude app ging die ze was vergeten te verwijderen. Maar waarom zou je überhaupt nog een datingapp op je telefoon hebben als je een relatie hebt?
R.
Hoezo een ‘zakendiner’ met kreeft en champagne?

Een ‘oude app’ die ineens midden in de nacht weer leven geeft? Dat klinkt ongeveer net zo geloofwaardig als een ex die 'alleen wil praten'. Geef haar één kans om het netjes uit te leggen. Vraag droogjes of je haar even moet helpen met verwijderen. Als ze nerveus wordt of met vage verhalen komt, weet je eigenlijk al genoeg. Vraag jezelf ook af: hoe zou zij reageren als het andersom was? Wat als jóuw telefoon ineens een datingmelding gaf?
Dag Lieve, Mijn man en ik hebben een gezamenlijke rekening. Laatst zag ik daar een afschrijving van een van de duurste visrestaurants van de stad. Op een dinsdagavond. Terwijl ik thuis op de bank zat met een gebakken visje. Hij zegt dat het gewoon een zakendiner was. Maar ik weet wie zijn collega’s zijn: mannen die liever bitterballen eten dan oesters sabreren. Dus waarom kreeft — en vooral met wie? Mirella uit B.
Tja, dat is natuurlijk de hamvraag. Natuurlijk, het kán onschuldig zijn. Maar dan wel opvallend romantisch voor een doordeweekse avond. Vraag quasi-nonchalant: ‘Hoe was dat etentje eigenlijk? Zat Ton van Sales er ook bij, of was het weer die ene collega waar je zo goed mee klikt?’ Let dan vooral vop zijn gezicht. Hij hoeft niet meteen te blozen, zweten is ook al een teken. En als je het écht niet vertrouwt? Stel dan voor om de volgende keer mee te gaan. Zijn reactie zal alles zeggen. Misschien wel meer dan het bonnetje.
Hi Lieve,
Mijn vriendin heeft dus zo’n bijverdienste waar ik eerst om moest lachen. Ze verkoopt haar gedragen lingerie online. Oké, prima, haar zaak. Maar nu kwam ik erachter dat ze ook míjn gedragen boxershorts verkoopt. Aan een of andere vieze vent, zo’n fetisjist, op internet. Voor €50 per stuk. Ze haalt ze gewoon uit m’n wasmand en zegt dat ze ‘extra lekker ruiken als ik heb gesport’. Toen ik zei dat ik dat echt ranzig vond, zei ze dat ik me aanstel. Maar ik wil gewoon niet dat er een vreemde aan m’n onderbroek zit te snuffelen. Carlos
Als iemand geld verdient aan jouw onderbroeken zonder dat jij het weet, is dat niet ondernemend, maar gewoon heel erg raar. Zeg het simpel: 'Ik vind dit echt niet chill. Als jij geld wil verdienen, prima. Maar
doe het dan met je eigen sokken of weet ik veel, maar niet met mijn was.' En als ze dan nog zegt dat jij je aanstelt?
Dan is de vraag niet alleen: 'Hoe stop ik dit?', maar ook: 'Waarom ben ik samen met iemand die geen grenzen snapt?' ■





„Aan een of andere vieze vent”



De prostaat is geen spiritueel geheim voor tantratypes, maar gewoon een klier - ter grootte van een walnoot - net onder de blaas. Je bereikt ’m via de anus, en ja: hij is gevoelig. Waarom noemen ze het de mannelijke G-spot? Omdat prostaatstimulatie bij sommige mannen leidt tot een intens orgasme, soms zelfs zonder aanraking van de penis. Dus waarom doet niet iedereen het? Omdat er schaamte omheen hangt. Maar de prostaat heeft niks met geaardheid te maken. Het is gewoon een deel van het mannelijk lijf. En wie ’m durft te ontdekken, kan nog weleens verrast worden.


OOK EEN SEKSTIP? Mail naar: lieve@dend.nl


Lente en de zomer is de tijd om te trouwen, om je wederzijdse liefde te bezegelen. We geven jullie de gelegenheid om dé foto met de lezers van DenD te delen. De leukste plaatsen we in de volgende editie op deze pagina. Het is als de kers op een taart. Is het geen leuke verrassing als je dit moment terugziet in je favoriete blad? Mail een trouwfoto en jouw verhaal naar de redactie: post@dend.nl.









ZEG JA… TEGEN
MIJN STAPEL
TROUWKAARTJES!
Ik heb een aantal trouwannonces in mijn bezit en zou het fijn vinden als ik er iemand blij mee kan maken. Kan ik er iemand een plezier mee doen? Marina van Voorst marinavanvoorst@gmail.com



n



Heeft u restjes painting-materiaaldiamondliggen waar u niets meer mee doet? Rond of vierkant maakt niet uit: ik maak er kaarten en kerst- of paasornamentjes van, en ook kleine cadeautjes. Alles is welkom! Esmeralda de Vrind
Riek Blokland-Paterlaan 6, 1183 WJ Amstelveen


Ze waren ooit overal: op tv, in de bladen, op rode lopers met een kapsel dat geen krul te veel had. En toen: stilte. In onze rubriek Was dat niet die van…? duiken we in het post-glamourleven van vergeten sterren. Deze maand: Mariska Hulscher (61), tegenwoordig: Mariska van der Klis.



e i s. h Hul

s in de bladen. RTL 4, Lookin de wet; hoorde. Tot ze verdween gereg Ma
Ze woont in Den Haa ze k de Pla En liefde. pelg die de c loo doo
Ze was een vaste prik in het Hilversumse ecosysteem. Mariska Hulscher stond voor snelle tv, liefde in schema’s en relatieadvies LookingGood,Wat zegt zij was de vrouw die wist hoe het hoorde. Tot ze verdween. Van tv, van covers, van dat zorgvuldig geregisseerde imago. Tegenwoordig heet ze Mariska van der Klis. Ze woont in Den Haag en wandelt. Na een pijnlijke relatiebreuk liep ze duizend kilometer over de Via de la Plata. Daar schreef ze een boek over: Fin Finisterre. En ja, er is een nieuwe Oscar. Ook een pelgrim. De vrouw die vroeger op hakken de camera in keek, loopt nu fluitend door zon en regen. En eerlijk: ze heeft nog steeds de pas erin.
En ee nog ste




Ik verzamel postzegels, zowel uit Nederland als uit het buitenland. Heeft u nog oude postzegels liggen die u niet meer gebruikt?
Masoud Nematollahi

Dan houd ik mij van harte aanbevolen. De portokosten worden uiteraard vergoed.
E-mail: masoud_ne@hotmail.com

Ik ben voor mijn collectie Laurel en Hardypoppetjes op zoek naar ‘de dikke en de dunne’ in Feyenoordshirt. In kringloopwinkels en op rommelmarkten kom ik ze helaas niet tegen. Er is een serie verschenen in shirts van gerenommeerde voetbalclubs. Alleen: die van Feyenoord ontbreken nog in mijn collectie. Misschien zijn er ook exemplaren van Laurel en Hardy in omloop, gekleed in een RBCshirt. Ook die zijn welkom!
Jaap Pleij
E-mail: jaap.pleij@telfort.nl
U










STICK (Apple TV+) 2 SIRENS (Netfl ix)
3 SQUID GAME, SEIZOEN 3 (Netfl ix)


*** Podcast van de maand *** WAAR IS SARAH?


Mijn collega én beste vriendin Barbara is jarig op 20 augustus. Ik kan me geen beter cadeau voorstellen dan haar grootste droom uit laten komen: een plekje in deze rubriek. Barbara is namelijk een hardcore Ditjes & Datjes-fan. Ik hoef het blad vaak niet eens meer mee te nemen; ze praat me in haar tomeloze enthousiasme al bij over de sappigste details. Ze doet het gros van haar boodschappen bij Dirk aan de Torenstraat in Den Haag. En omdat ze al vaker hardop heeft gefantaseerd over 'Groeten aan Dirk', leek dit me een perfecte manier om haar verjaardag onvergetelijk te maken. Bas Brouwer






Reddingswerker Rob redde in 2016 een baby uit zee. In deze bekroonde podcast volgt Laura Stek zijn zoektocht naar het meisje, en naar de reden waarom hij haar niet kan loslaten.


Als u wilt reageren op de verhalen in DenD, of als u iets speciaals zoekt voor uw verzameling, dan kan dat via het volgende e-mailadres: post@dend.nl



Ga voor oplossingen van de puzzels naar: dend.nl/puzzel en voor de prijzen naar: dend.nl/winnen

Ons redactieadres voor brieven en kaarten is: DenD
Donauweg 10 1043 AJ Amsterdam





















Super absorberend en scheurbestendig









Kan in de GFT-bak en op een eigen composthoop

Voor een zachtere wereld



door MARIEKE VAN DER BURGT
Gedragstherapeut voor dieren







Ongetwijfeld bekend: de look-a-like sledehond die zich tijdens het uitlaten letterlijk en figuurlijk ophangt aan zijn eigen lijn. Misschien loopt er zelfs eentje thuis rond. Wie het trekken wil afleren, moet eerst begrijpen: wat levert het eigenlijk op voor de hond?
Een hond blijft bepaald gedrag alleen vertonen als het hem iets oplevert. Zo simpel is het. Is er voordeel te behalen, dan ontstaat het trekken aan de lijn. Wat er in het vizier ligt (een andere hond, een interessant geurtje, of gewoon vooruit willen) is op dat moment belangrijker dan het ongemak van een gespannen halsband in zijn nek.
Geweldige resultaten
Honden lopen van nature sneller dan een mens, dus het einde van de lijn is al snel bereikt. De



Vorig jaar werden de pups geboren.
De Franse bulldog van de Amerikaanse rapper Megan Thee Stallion is inmiddels meer influencer dan huisdier. Met 514.000 volgers op Instagram (Zijn account: @ frenchie4oe) en een designerhalsband om de nek levert elk kiekje hem zo’n €6432 op. En dat terwijl hij meestal alleen maar een beetje ligt te slapen met z’n tong uit z’n bek. Sinds juni 2024 mag Foe zich bovendien vader noemen. Drie pups worden uitgebreid getoond op Instagram alsof het om kleine kroonjuwelen gaat.

Foe is het paradepaardje binnen Megans beestenboel, waar ook een pitbull, een kat en een schildpad toe behoren. Maar niemand trekt de spotlights zoals hij.







Het uitgangspunt is dat de hond de strakheid van de lijn regelt en niet u. Zodra uw hond trekt, gaat u stilstaan. Op het moment dat de spanning van de lijn weg is, vervolgt u weer de wandeling. Probeer in het begin uw wandeltempo aan te passen aan het tempo van de hond, zodat het voor uw hond iets makkelijker wordt om niet te trekken aan de lijn. Beloon uw hond wanneer hij netjes met u meeloopt.

DenD-Dierenwereld werkt samen met

belangrijkste motivatie om te blijven trekken, en vaak zelfs steeds harder, is dat de hond met zijn getrek keer op keer geweldige resultaten boekt. Op afstand verschijnt er bijvoorbeeld een andere hond: 'Hé, een speelkameraadje, daar wil ik heen!' De begeleider heeft eigenlijk ook wel zin om met de andere hondeneigenaar te kletsen en laat zich gewillig meetrekken. Zo leert de hond: wie trekt, komt waar hij wil zijn. Het eerste succes, en de versterking van het trekgedrag, is binnen. ■
Hé, een speelkameraadje, daar wil ik heen!









Dit is Nova (bijna vijf), een Friese Stabij uit Emst. Ze kwam als een soort supernova ons leven binnengeknald: knetterveel energie, chaos, liefde en likjes. Bij een natuurfilm over ruimte-explosies dacht ik ineens: dát is haar naam. Nova. Ze is lief, aanhankelijk, mooi en totaal niet van het type hondenmens: luisteren doet ze wanneer het háár uitkomt. Ze weet precies wat wel en niet mag, maar kiest liever voor de ondeugende route. Wil ze iets opgraven in de tuin? Dan loopt ze er eerst héél casual langs, zogenaamd onschuldig. Wij weten dan al hoe laat het is. Ze houdt van spelen, van aandacht, van snoepjes en van onverwacht je veters likken. Nova is niet per se de slimste, maar ze is wel de leukste.

Ook met uw huisdier in DenD?
Mail naar post@dend.nl
Een andere methode is de methode 'trekken = omdraaien'. Op het moment dat de hond trekt, draait u meteen om en zorgt u ervoor dat uw hond niet komt waar hij naartoe wilde trekken. U mag beide methodes door elkaar gebruiken. Het zal best even duren voordat uw hond doorheeft wat de bedoeling is. Maar als hij de oefening eenmaal begrijpt, zult u zien dat de vorderingen snel gaan.


In het begin zult u waarschijnlijk geen stap verzetten of de lijn staat alweer strak. Blijf heel consequent en geduldig, en ga stilstaan of draai om. Laat iedereen die de hond uitlaat zich aan de gestelde regels houden! Op het moment dat de spanning van de lijn weg is, beloont u uw hond. Gebruik een lijn met een lengte van ongeveer anderhalve meter. Zorg dat u de lijn altijd even lang houdt. Hierdoor zal uw hond uiteindelijk leren hoeveel ruimte hij heeft tijdens het wandelen. tinleygedragstherapie.nl












5-laags extra grote vellen





5-laags extra grote vellen l ht ll 3 l g fl


3-laags fluweelzachte vellen




















































































ROEM! Scheur mee naar garage De Gierende Band en vlieg uit de bocht met de hilarische familie Bots. Het nieuwe boek van Tosca Menten allereerste plakboek van Turbo Teun: vol maffe fantasie, bizarre humor en perfect voor alle jonge racefans vanaf negen jaar. Teun Bots is de enige in zijn familie die het kartvirus niet heeft. Hij is dol op oude auto’s en de geur van olie en droomt ervan om automonteur te worden. Snel gaan vindt hij juist eng! Dan organiseert Steentjesdorp een
ee naar de Band cht met de nieuwe n is het Turbo bizarre le r. Teun milie ft. Hij e geur om an een


grote kartwedstrijd om het vernieuwde Oude Circuit te openen. Nichtje Vlam is topfavoriet, maar de nieuwe burgemeester en zijn zoon zitten vol vieze trucjes. Tijdens de Grote Prijs van Steentjesdorp gaat het volledig mis in de beruchte Paperclipbocht,Ploertige en ineens is het aan Teun om de familie-eer te redden. Dat betekent dat hij zijn angsten moet overwinnen en sneller moet gaan dan hij durft! Een avontuur vol vaart, vieze trucs en snelle grappen, met in de hoofdrollen: antiheld Teun, turbo-nichtje Vlam, de goedzak Oom Engin en een oma waar je beter niet mee spot.



Drie jaar geleden begon Quintyvan Koert (28) haar eigen studio in haar slaapkamer bij haar ouders in het Westland. Ze had geen geld, maar wel een heleboel fantasie. Ze tekende, schreef en gaf zélf een prentenboek uit over Mello: een vrolijke ijsbeer die gek is op ijsjes. Kinderen vonden het boek geweldig. Daarom bedacht Quinty een plan: wat als Mello écht tot leven zou komen? Ze ging aan de slag met poppen, liedjes, scripts en decors. De ijsjesbeer werd een echte pop en samen met een klein team werkte ze jarenlang aan haar droom:


B e n K j j : g g d d



Quinty heeft haar eigen kinderserie: Camping Mello.
een echte kinderserie! En die is er nu: Camping Mello. De serie gaat over een camping aan zee, waar Mello avonturen beleeft met zijn vrienden Quin (gespeeld door Quinty zelf), Jut en Berrie. Camping Mello is geregisseerd door Ilse Vocking (die ook Ernst, Bobbie en de rest maakte) en elke vrijdag verschijnt er een nieuwe aflevering op YouTube Kids. Quinty: „Ik wilde iets maken wat ook leuk is voor ouders. Zodat je niet hoeft weg te zappen zodra de kinderen iets aanklikken.”









VAN TANJA VA N TA N J A



DOBBEL VOUWEN


Uitgever: 999Games
Leeftijd: vanaf 8 jaar tot 99 jaar!
Spelers: 1 tot 4
Tijdens het kamperen in Noorwegen hebben we heel wat spelletjes gespeeld. Op regenachtige dagen kwamen vooral Rummikub en Trivia Games op tafel, maar we probeerden ook het spel van @999games: Dobbel Vouwen. Dat is een zogeheten roll & write-spel: je gooit met dobbelstenen en vult daarna je scoreblad in. Dobbel Vouwen heeft daarbovenop nog iets leuks: je kunt de hoeken van je scoreblad omvouwen om extra bonussen vrij te spelen. Ik ben echt fan! Roll & write is sowieso mijn favoriete spelsoort, en deze is vernieuwend én handig door het compacte formaat en de verrassende extra laag. Er zijn vier moeilijkheidsniveaus, dus je raakt er niet snel op uitgekeken. Ook is er ook een solo-modus, en die vind ik minstens zo leuk als de versie met meerdere spelers. Insta: boardgame_review_tanja
De woorden hieronder zitten in alle richtingen verstopt. Sommige letters kunnen vaker gebruikt worden. Streep alle woorden af die je hebt gevonden. De letters die overblijven, zet je achter elkaar in de lege hokjes. Dat is de oplossing.
Juf: Waar is je huiswerk. Piet: Ik heb het opgegeten. Juf: Waarom? Piet: De hond sliep.
Ben jij weleens geprikt door een mug of wesp? Dat je dan de hele tijd moet krabben?
Met heat-it is dat snel voorbij! Het werkt supersimpel: je steekt het kleine apparaatje in de telefoon van je ouders, zet het even op de plek van de beet en… weg jeuk! Het wordt even warm, maar dat helpt juist.
R opvakantiein
Zo voelt je huid snel weer fijn. Handig voor op vakantie, in het bos of op de camping. En ook papa of mama kunnen het gebruiken, want muggen prikken iedereen. heatit.nl

DenD verloot 2X Heat-it. Stuur de goede oplossing van de woordzoeker t/m 25 augustus 2025 in op DenD.nl/puzzel om kans te maken.



Aan de rand van Den Haag, verscholen naast park Hertenkamp, ligt Hotel Riva. Geen standaard zakenhotel, maar een moderne verblijfplek met oog voor sfeer. Luxe kamers, warme tinten, dikke kussens en uitzicht op een vijver met - jawel - herten. Wie er even tussenuit wil, maar niet ver, zit hier goed. ’s Avonds wacht het restaurant: een wereldreis in gangen. Van oosterse smaken en Franse klassiekers tot verse vis en huisgemaakte desserts. rivahotel.nl
DenD verloot een gratis overnachting inclusief ontbijt en diner in Wereldrestaurant Samen, voor twee personen in het viersterren Riva Hotel. Stuur de goede oplossing van de woordzoeker in op DenD.nl/puzzel en maak kans.


DenD verloot een 14 karaat gouden armband van Cataleya Jewels. Stuur de oplossing van de puzzel in op DenD.nl/puzzel om kans te maken.
Daphne van Maxgoud Goudinkoop, bekend van televisie (o.a. VARA Kassa, waar ze de hoogste undercover goudprijs scoorde), geeft weer wat moois weg: een 14 karaat gouden armband van Cataleya Jewels. Stijlvol, waardevol én van echt goud. Maxgoud is dé specialist in de inkoop van goud en zilver, en staat bekend om haar transparante werkwijze, hoge uitbetalingsprijzen en maxgoud.com
Druppelvormig en fonkelend bij elke beweging; deze zilveren oorbellen van Otazu zijn het soort sieraad waar je meteen complimenten mee oogst. Gemaakt van 925 zilver en bezet met Swarovski-stenen zijn ze vrouwelijk, feestelijk én tijdloos. Perfect bij een strakke knot en een beetje lef. juwelierjansen.nl
uitstekende service. ma m















DenD trakteert op Swarovski-oorbellen van Otazu. Stuur de oplossing van de puzzel in opDenD.nl/puzzel om kans te maken.
De oplossing van de Zweedse puzzel kun je t/m 25 augustus 2025 online invullen op dend.nl/puzzel of per post sturen naar: redactie DenD, Donauweg 10, 1043 AJ Amsterdam.

Het team van Dirk Drachten nam de prijs in ontvangst: Dirk van den Broek is voor de vierde keer op rij de beste supermarkt.
Dirk behoudt de eerste plaats in de lijst van landelijke supermarktformules. Met een gemiddelde waarderingsscore van 7,64 scoort Dirk opnieuw boven het landelijke gemiddelde.
Dirk van den Broek is opnieuw uitgeroepen tot beste landelijke supermarkt. Dat blijkt uit het YouGov Zomerrapport 2025. De klantenkring van Dirk is het afgelopen jaar gegroeid: 31,5% van de Nederlandse huishoudens bezoekt inmiddels een Dirk-winkel. Ook de klantentrouw is toegenomen, van 14,6% naar 15,3%. Een op de drie Nederlanders doet zijn boodschappen bij een Dirk.
Dirk blijft uitblinken op aspecten die voor zijn klanten het belangrijkst zijn: lage prijzen en aanbiedingen, aldus het zomerrapport. In het YouGov Zomerrapport 2025 kreeg de keten het hoogste rapportcijfer van alle supermarktformules: een 7,64. Marcel Huizing, directeur Dirk van den Broek
supermarkten, is blij met de eerste plaats voor Dirk. „Want we zijn voor de vierde (!) keer op rij uitgeroepen tot de beste landelijke supermarkt van Nederland. In dit rapport hebben we het hoogste rapportcijfer van alle landelijke supermarkten. Een heel indrukwekkende prestatie van al onze collega’s.” Dirk wordt geroemd om de lage prijzen en aantrekkelijke aanbiedingen. Volgens de jury steekt Dirk er met kop en schouders bovenuit!
„Na het winnen van het Kerstrapport 2023, Zomerrapport 2024 én het Kerstrapport 2024, slagen we weer met vlag en wimpel.
Het bewijs dat we constant onze beloftes waarmaken en onze klanten bieden wat ze nodig hebben”, zegt Marcel Huizing.
Kort daarvoor kwam ook het supermarktKOMPAS-onderzoek naar buiten. Daarin werd Dirk voor de derde keer op rij uitgeroepen tot beste landelijke supermarkt. Consumenten roemen de keten om de lage prijzen, de versproducten en opvallend goede folders. ■


























































































DenD en Oranje Boven zijn de grootste gratis redactioneel onafhankelijke familiebladen van Nederland met een oplage van 650.000 exemplaren. Gratis meenemen bij de meer dan 130 supermarkten van Dirk van den Broek en 44 Dirck3-slijterijen.
Ga naar www.dend.nl voor het actuele entertainment- en royaltynieuws.
Uitgever
Brookland Productions, Sassenheim
Concept, realisatie en redactie
Trusted Media Publishers
Fotografie
Johannes Dalhuijsen, ANP/ Hollandse Hoogte o.a.: Edwin Jansen, Anneke Jansen, Patrick Harderwijk en Robin Utrecht, Flickr, Unsplash, Instagram, Facebook, Netflix, Jurjen Donkers
Adres redactie DenD




Trusted Media Publishers
Donauweg 10 1043 AJ Amsterdam
43 J













DenD wo alle Dirk v en Dirck3
DenD wordt verspreid via: alle Dirk van den Broek-supermarkten en Dirck3-slijterijen
Niets in deze uitgave mag, in welke vorm en op welke wijze dan ook, worden overgenomen zonder voorafgaande schriftelijke toestemming van de uitgever. Hoewel DenD met de grootst mogelijke zorgvuldigheid wordt samengesteld, staan uitgever en redactie niet in voor eventuele onvolkomenheden in de inhoud en kunnen hiervoor niet aansprakelijk worden gesteld. Niet alle in de advertenties genoemde producten zijn verkrijgbaar in de winkels die hieronder worden genoemd.
Niets in dez welke voorafgaan uitgever. H zorgvuldigh en in de inhou ges die hierond

Esschert Design: intratuin.nl
HK Living: hkliving.com
House of Marley: marley.nl
Leopold Vienna: leopold-vienna.nl
Loberon: loberon.nl
Unique Living: intratuin.nl

















































































































































































































